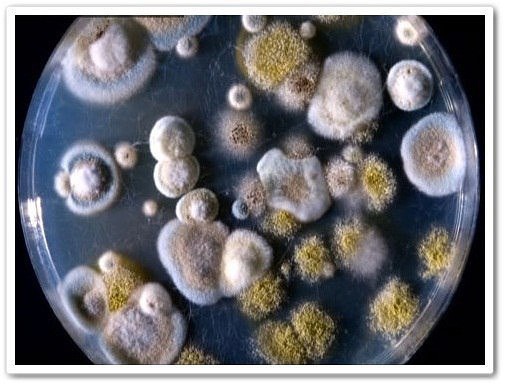

Авторизация
Поиск по сайту
Форум
Сообщества
Тесты
Статистика
Сейчас на сайте (124)
124 гость(ей)
Последние посетившие сайт
Новые пользователи
Самые дружные пользователи
???? MD: Если Лео Месси вернется в «Барселону», клуб...
2 лет назад от Я там, где «Барселона» | Barcelona
???? MD: Если Лео Месси вернется в «Барселону», клуб ожидает, что он согласится на меньшую зарплату и другую роль в команде и раздевалке; с уважением к лидерам, появившимся за время его отсутствия.
???? Ничья. Барселона 0 — 0 Жирона???????? Верьте в Барсу!...
2 лет назад от Я там, где «Барселона» | Barcelona
???? Ничья. Барселона 0 — 0 Жирона
???????? Верьте в Барсу! Любите Барсу! Visca el Barça! Visca
Наш телеграм-канал: t.me/tg_barca
???????? Верьте в Барсу! Любите Барсу! Visca el Barça! Visca
Наш телеграм-канал: t.me/tg_barca

Дыхательные упражнения для расслабления...
2 лет назад от Сыроедение - Я ФРУКТОРИАНЕЦ
Дыхательные упражнения для расслабления
Равномерное дыхание
Уровень сложности: низкий
Когда выполнять: в любое время или перед сном
Техника: вдохни через нос и посчитай до четырех, выдохни и снова посчитай до четырех. Продолжай выполнять в том же темпе.
Брюшное дыхание
Уровень сложности: низкий
Когда выполнять: в любой стрессовой ситуации
Техника: удерживая одну руку на груди, а другую на животе, глубоко вдохни через нос, расправляю диафрагму. Выполняй по 6-10 глубоких вдохов в минуту на протяжении 10 минут.
Чередующееся ноздревое дыхание
Уровень сложности: средний
Когда выполнять: при необходимости сосредоточиться и взбодриться
Техника: займи удобную медитативную позу, прижми большим пальцем правой руки правую ноздрю и глубоко вдохни через левую. Закончив вдох, прижми левую указательным пальцем и выдохни через правую. Продолжай в том же порядке.
Неравномерное дыхание
Уровень сложности: высокий
Когда выполнять: после пробуждения, при необходимости взбодриться
Техника: выполни медленный глубокий вдох, а затем мощный выдох при поддержке нижней части живота. Выполни 10 раз.
Прогрессивная релаксация
Уровень сложности: низкий
Когда выполнять: в любых ситуациях
Техника: закрой глаза и поочередно напрягай и расслабляй каждую группу мышц по 2-3 секунды. Начни с пальцев ног, затем переходи к коленям, бедрам, ягодицам, груди, рукам, шее, челюсти и даже глазам. Все это время поддерживая глубокое медленное дыхание
Равномерное дыхание
Уровень сложности: низкий
Когда выполнять: в любое время или перед сном
Техника: вдохни через нос и посчитай до четырех, выдохни и снова посчитай до четырех. Продолжай выполнять в том же темпе.
Брюшное дыхание
Уровень сложности: низкий
Когда выполнять: в любой стрессовой ситуации
Техника: удерживая одну руку на груди, а другую на животе, глубоко вдохни через нос, расправляю диафрагму. Выполняй по 6-10 глубоких вдохов в минуту на протяжении 10 минут.
Чередующееся ноздревое дыхание
Уровень сложности: средний
Когда выполнять: при необходимости сосредоточиться и взбодриться
Техника: займи удобную медитативную позу, прижми большим пальцем правой руки правую ноздрю и глубоко вдохни через левую. Закончив вдох, прижми левую указательным пальцем и выдохни через правую. Продолжай в том же порядке.
Неравномерное дыхание
Уровень сложности: высокий
Когда выполнять: после пробуждения, при необходимости взбодриться
Техника: выполни медленный глубокий вдох, а затем мощный выдох при поддержке нижней части живота. Выполни 10 раз.
Прогрессивная релаксация
Уровень сложности: низкий
Когда выполнять: в любых ситуациях
Техника: закрой глаза и поочередно напрягай и расслабляй каждую группу мышц по 2-3 секунды. Начни с пальцев ног, затем переходи к коленям, бедрам, ягодицам, груди, рукам, шее, челюсти и даже глазам. Все это время поддерживая глубокое медленное дыхание

ТАТЬЯНА ЧЕРНИГОВСКАЯ: «НЕ НАЧИНАЙТЕ УЧИТЬ РЕБЕНКА...
2 лет назад от Сыроедение - Я ФРУКТОРИАНЕЦ
ТАТЬЯНА ЧЕРНИГОВСКАЯ: «НЕ НАЧИНАЙТЕ УЧИТЬ РЕБЕНКА СЛИШКОМ РАНО»
Современные мамы и папы начинают развивать своих малышей буквально с пеленок. И полностью уверены в том, что делают все правильно. Но оказывается, это не столь важно. Гораздо важнее грамотно использовать ресурсы, которыми мы обладаем. Психолингвист, нейробиолог, профессор СПБГУ Татьяна Владимировна Черниговская в своей лекции «Как научить мозг учиться» рассказывает о том, почему мальчиков и девочек нужно учить по-разному и о секретах, которые сделают процесс обучения проще и понятнее.
Не начинайте учить ребенка слишком рано
Для детей очень важно начать учиться вовремя. Главная беда современного ребенка в тщеславных родителях. Когда мне говорят: «Я своего сына в два года начал учить читать», я отвечаю: «Ну и дурак!» Зачем это нужно? Он в два года еще не может этого делать. Его мозг к этому не готов. Если вы его надрессируете – он, конечно, будет и читать, и, может, даже писать, но у нас с вами другая задача.
Вообще, у детей огромный разброс в скорости развития. Есть такой термин – «возраст школьной зрелости». Он определяется так: одному ребенку 7 лет и другому тоже 7 лет, но один идет в школу, потому что его мозг к этому готов, а второму надо еще полтора года дома с мишкой играть и только потом садиться за парту.
По официальным данным, у нас более 40% детей имеют трудности с чтением и письмом по окончании начальной школы. И даже в 7 классе есть те, кто плохо читает. У таких детей вся когнитивная мощь мозга уходит на то, чтобы продраться через буквы. Поэтому если даже он и прочитывает текст, то понять смысл сил уже не хватило, и любой вопрос по теме поставит его в тупик.
Развивайте мелкую моторику
Перед нами стоит очень сложная задача: мы находимся на стыке между человеком, который писал по прописям и читал обычные книги, и человеком, который читает гипертексты, писать не умеет вообще, имеет дело с иконками и даже не набирает тексты. Важно понимать, что это – другой человек и у него другой мозг. Нам, взрослым, нравится этот другой мозг, и мы уверены, что никакой опасности в этом нет. А она есть. Если маленький ребенок, придя в школу, не учится письму, привыкая к мелким филигранным движениям ручки, если в детском саду он ничего не лепит, не вырезает ножницами, не перебирает бисер, то у него мелкая моторика не вырабатывается. А это именно то, что влияет на речевые функции. Если вы не развиваете у ребенка мелкую моторику, то не жалуйтесь потом, что его мозг не работает.
Слушайте музыку и приучайте к этому детей
Современные нейронауки активно изучают мозг в то время, когда на него воздействует музыка. И мы сейчас знаем, что когда музыка участвует в развитии человека в раннем возрасте, это сильно влияет на структуру и качество нейронной сети. Когда мы воспринимаем речь, происходит очень сложная обработка физического сигнала. Нам в ухо ударяют децибелы, интервалы, но это все физика. Ухо слушает, а слышит мозг. Когда ребенок обучается музыке, он привыкает обращать внимание на мелкие детали, отличать звуки и длительности между собой. И именно в это время формируется тонкая огранка нейронной сети.
Не разрешайте мозгу лениться
Не все люди на нашей планете гениальны. И если у ребенка плохие гены, то тут ничего не поделаешь. Но даже если гены хорошие, то этого все равно недостаточно. От бабушки может достаться великолепный рояль Steinway, но на нем надо учиться играть. Точно так же ребенку может достаться замечательный мозг, но если он не будет развиваться, формироваться, ограниваться, настраиваться – пустое дело, погибнет. Мозг киснет, если у него нет когнитивной нагрузки. Если вы ляжете на диван и полгода будете лежать, то потом вы не сможете встать. И с мозгом происходит абсолютно то же самое.
Я думаю, любому человеку понятно, что если бы Шекспир, Моцарт, Пушкин, Бродский и другие выдающиеся деятели искусства попробовали бы сдать ЕГЭ, они бы его провалили. И тест на IQ бы провалили. О чем это говорит? Только о том, что тест на IQ никуда не годится, потому что никто не сомневается в гениальности Моцарта, кроме сумасшедших.
Не затачивайте детей только под ЕГЭ
Есть такая карикатура, на ней изображены животные, которым предстоит залезть на дерево: обезьяна, рыбка и слон. Разные существа, некоторые из которых в принципе влезть на дерево не могут, однако, это именно то, что предлагает нам современная система образования в виде предмета нашей особенной гордости, ЕГЭ.
Я считаю, что это очень большой вред. Если, конечно, мы хотим приготовить к жизни людей, которые будут работать на конвейере, то это, безусловно, подходящая система. Но тогда мы должны сказать: все, мы на развитии нашей цивилизации ставим точку. Будем держать Венецию сколько можно, чтобы она не утонула, а новенького нам не надо, хватит уже шедевров, девать их некуда. А вот если мы хотим воспитывать творцов, то эта система – худшее, что можно было придумать.
Учите мальчиков и девочек по-разному
Говорить с мальчиками нужно кратко и конкретно. Для максимального эффекта они должны быть вовлечены в активную деятельность, им просто нельзя сидеть спокойно. У них столько энергии, что лучше всего постараться направить ее в мирное русло, дать выход, причем прямо во время занятий. Не запирайте их в маленьком замкнутом пространстве, дайте им простор и возможность двигаться. Кроме того, мальчикам нужно ставить больше реальных задач, придумывать состязания, а скучных письменных заданий давать меньше, от них нет никакого толку. А еще их обязательно нужно хвалить за любую мелочь. И вот еще один интересный факт: оказывается, мальчики должны воспитываться в более прохладных помещениях, чем девочки, потому что иначе они у вас во время занятия просто заснут.
Девочки же любят работать в группе, им нужен контакт. Они глядят в глаза друг другу и любят помогать учителю. Вот это очень важно: девочек не надо оберегать от падений и загрязнений, они должны испытывать «контролируемый риск». Есть возможность у нее упасть, пусть упадет и научится справляться с этим.
Девочки очень не любят резкие громкие разговоры, но требуют непременного эмоционального включения, а еще они любят цветной мир, то есть класс для занятий у девочек должен быть ярким.
Внимательный индивидуальный подход может из двоечника сделать отличника. Не все двоечники по-настоящему двоечники, некоторые из них – Леонардо Да Винчи, навсегда погибшие благодаря гениальным усилиям учителей.
Делайте перерывы
Обычно считается, что, если в процессе выучивания ребенок что-то забыл – это плохо, отвлекся – плохо, перерыв сделал – тоже плохо, а если уснул – вообще кошмар. Это все неправда. Все эти перерывы – не просто не помехи для запоминания материала и обработки информации, а наоборот, помощь. Они дают возможность мозгу уложить, усвоить полученную информацию. Лучшее, что мы можем сделать, если нам что-то нужно срочно выучить прямо к завтрашнему дню, это прочитать прямо сейчас и быстро лечь спать. Основная работа мозга происходит в то время, когда мы спим.
Для того, чтобы информация попала в долговременную память, нужно время и определенные химические процессы, которые происходят как раз во сне.
Постоянное напряжение от того, что вы что-то не успели, что-то не получилось, опять ошибки, ничего не выходит – это худшее, что вы можете себе причинить. Нельзя бояться ошибок. Чтобы учиться было легче, нужно осознать, что обучение идет всегда, а не только за письменным столом. Если человек просто сидит за письменным столом и делает вид, что он учится – ничего полезного не выйдет.
Татьяна Владимировна Черниговская
Психолингвист, нейробиолог, профессор СПБГУ
Современные мамы и папы начинают развивать своих малышей буквально с пеленок. И полностью уверены в том, что делают все правильно. Но оказывается, это не столь важно. Гораздо важнее грамотно использовать ресурсы, которыми мы обладаем. Психолингвист, нейробиолог, профессор СПБГУ Татьяна Владимировна Черниговская в своей лекции «Как научить мозг учиться» рассказывает о том, почему мальчиков и девочек нужно учить по-разному и о секретах, которые сделают процесс обучения проще и понятнее.
Не начинайте учить ребенка слишком рано
Для детей очень важно начать учиться вовремя. Главная беда современного ребенка в тщеславных родителях. Когда мне говорят: «Я своего сына в два года начал учить читать», я отвечаю: «Ну и дурак!» Зачем это нужно? Он в два года еще не может этого делать. Его мозг к этому не готов. Если вы его надрессируете – он, конечно, будет и читать, и, может, даже писать, но у нас с вами другая задача.
Вообще, у детей огромный разброс в скорости развития. Есть такой термин – «возраст школьной зрелости». Он определяется так: одному ребенку 7 лет и другому тоже 7 лет, но один идет в школу, потому что его мозг к этому готов, а второму надо еще полтора года дома с мишкой играть и только потом садиться за парту.
По официальным данным, у нас более 40% детей имеют трудности с чтением и письмом по окончании начальной школы. И даже в 7 классе есть те, кто плохо читает. У таких детей вся когнитивная мощь мозга уходит на то, чтобы продраться через буквы. Поэтому если даже он и прочитывает текст, то понять смысл сил уже не хватило, и любой вопрос по теме поставит его в тупик.
Развивайте мелкую моторику
Перед нами стоит очень сложная задача: мы находимся на стыке между человеком, который писал по прописям и читал обычные книги, и человеком, который читает гипертексты, писать не умеет вообще, имеет дело с иконками и даже не набирает тексты. Важно понимать, что это – другой человек и у него другой мозг. Нам, взрослым, нравится этот другой мозг, и мы уверены, что никакой опасности в этом нет. А она есть. Если маленький ребенок, придя в школу, не учится письму, привыкая к мелким филигранным движениям ручки, если в детском саду он ничего не лепит, не вырезает ножницами, не перебирает бисер, то у него мелкая моторика не вырабатывается. А это именно то, что влияет на речевые функции. Если вы не развиваете у ребенка мелкую моторику, то не жалуйтесь потом, что его мозг не работает.
Слушайте музыку и приучайте к этому детей
Современные нейронауки активно изучают мозг в то время, когда на него воздействует музыка. И мы сейчас знаем, что когда музыка участвует в развитии человека в раннем возрасте, это сильно влияет на структуру и качество нейронной сети. Когда мы воспринимаем речь, происходит очень сложная обработка физического сигнала. Нам в ухо ударяют децибелы, интервалы, но это все физика. Ухо слушает, а слышит мозг. Когда ребенок обучается музыке, он привыкает обращать внимание на мелкие детали, отличать звуки и длительности между собой. И именно в это время формируется тонкая огранка нейронной сети.
Не разрешайте мозгу лениться
Не все люди на нашей планете гениальны. И если у ребенка плохие гены, то тут ничего не поделаешь. Но даже если гены хорошие, то этого все равно недостаточно. От бабушки может достаться великолепный рояль Steinway, но на нем надо учиться играть. Точно так же ребенку может достаться замечательный мозг, но если он не будет развиваться, формироваться, ограниваться, настраиваться – пустое дело, погибнет. Мозг киснет, если у него нет когнитивной нагрузки. Если вы ляжете на диван и полгода будете лежать, то потом вы не сможете встать. И с мозгом происходит абсолютно то же самое.
Я думаю, любому человеку понятно, что если бы Шекспир, Моцарт, Пушкин, Бродский и другие выдающиеся деятели искусства попробовали бы сдать ЕГЭ, они бы его провалили. И тест на IQ бы провалили. О чем это говорит? Только о том, что тест на IQ никуда не годится, потому что никто не сомневается в гениальности Моцарта, кроме сумасшедших.
Не затачивайте детей только под ЕГЭ
Есть такая карикатура, на ней изображены животные, которым предстоит залезть на дерево: обезьяна, рыбка и слон. Разные существа, некоторые из которых в принципе влезть на дерево не могут, однако, это именно то, что предлагает нам современная система образования в виде предмета нашей особенной гордости, ЕГЭ.
Я считаю, что это очень большой вред. Если, конечно, мы хотим приготовить к жизни людей, которые будут работать на конвейере, то это, безусловно, подходящая система. Но тогда мы должны сказать: все, мы на развитии нашей цивилизации ставим точку. Будем держать Венецию сколько можно, чтобы она не утонула, а новенького нам не надо, хватит уже шедевров, девать их некуда. А вот если мы хотим воспитывать творцов, то эта система – худшее, что можно было придумать.
Учите мальчиков и девочек по-разному
Говорить с мальчиками нужно кратко и конкретно. Для максимального эффекта они должны быть вовлечены в активную деятельность, им просто нельзя сидеть спокойно. У них столько энергии, что лучше всего постараться направить ее в мирное русло, дать выход, причем прямо во время занятий. Не запирайте их в маленьком замкнутом пространстве, дайте им простор и возможность двигаться. Кроме того, мальчикам нужно ставить больше реальных задач, придумывать состязания, а скучных письменных заданий давать меньше, от них нет никакого толку. А еще их обязательно нужно хвалить за любую мелочь. И вот еще один интересный факт: оказывается, мальчики должны воспитываться в более прохладных помещениях, чем девочки, потому что иначе они у вас во время занятия просто заснут.
Девочки же любят работать в группе, им нужен контакт. Они глядят в глаза друг другу и любят помогать учителю. Вот это очень важно: девочек не надо оберегать от падений и загрязнений, они должны испытывать «контролируемый риск». Есть возможность у нее упасть, пусть упадет и научится справляться с этим.
Девочки очень не любят резкие громкие разговоры, но требуют непременного эмоционального включения, а еще они любят цветной мир, то есть класс для занятий у девочек должен быть ярким.
Внимательный индивидуальный подход может из двоечника сделать отличника. Не все двоечники по-настоящему двоечники, некоторые из них – Леонардо Да Винчи, навсегда погибшие благодаря гениальным усилиям учителей.
Делайте перерывы
Обычно считается, что, если в процессе выучивания ребенок что-то забыл – это плохо, отвлекся – плохо, перерыв сделал – тоже плохо, а если уснул – вообще кошмар. Это все неправда. Все эти перерывы – не просто не помехи для запоминания материала и обработки информации, а наоборот, помощь. Они дают возможность мозгу уложить, усвоить полученную информацию. Лучшее, что мы можем сделать, если нам что-то нужно срочно выучить прямо к завтрашнему дню, это прочитать прямо сейчас и быстро лечь спать. Основная работа мозга происходит в то время, когда мы спим.
Для того, чтобы информация попала в долговременную память, нужно время и определенные химические процессы, которые происходят как раз во сне.
Постоянное напряжение от того, что вы что-то не успели, что-то не получилось, опять ошибки, ничего не выходит – это худшее, что вы можете себе причинить. Нельзя бояться ошибок. Чтобы учиться было легче, нужно осознать, что обучение идет всегда, а не только за письменным столом. Если человек просто сидит за письменным столом и делает вид, что он учится – ничего полезного не выйдет.
Татьяна Владимировна Черниговская
Психолингвист, нейробиолог, профессор СПБГУ

Не кормите грибов в организме… Грибы — это другая...
2 лет назад от Сыроедение - Я ФРУКТОРИАНЕЦ
Не кормите грибов в организме…
Грибы — это другая цивилизация, при этом самая древняя, практически вечная субстанция. Вытравить грибы из организма человека очень-очень сложно. Если грибок уже заселился, и, условно говоря, развил свою грибницу, то возникают достаточно сложные проблемы.
Грибы бывают разные. Бывают, якобы благородные грибы, бывают низшие грибы (называются плесень). У грибов очень много марок, очень много названий, более 50 видов. Есть грибы малотоксичные, есть грибы лесные, есть низшие, есть высшие.
Высших грибов целый класс — это китайский кордицепс, рейкет. В чем заключается смысл гриба? Смысл заключается в том, что у него есть генетический код и это не единичная особь, а особь, которая живет колониями. При чем, между этими колониями существует точная взаимосвязь сегментов. То есть каждый грибной элемент связан с другими грибными элементами тысячами сегментных связей.
Если мы хотим, чтобы наш организм был свободен от грибов, единственное, что мы можем, это не давать ему пищу. Потому что, если в нашем организме достаточно пищи для грибов, то они в нем будут. Вот, например, в хлебнице лежит хлеб. На нем образовалась плесень. Если вы хлеб уберете и оставите плесень, то постепенно эта плесень погибнет.
Потому что ей нечего будет кушать. Она высохнет, не размножится, потому что для размножения ей нужны питательные вещества. Питается плесень в основном белковыми продуктами, потому что ей нужны аминокислоты.
Вот, например, мы берем муку, добавляем сахар, масло — энергию, добавляем воду, добавляем дрожжи — это вот и есть плесень особого рода — хлебная плесень.
Дальше мы этой плесени даем температуру, обязательно 37, потом даем ей особую влажность и кислород. И тогда она начинает размножаться, реанимироваться. Причем, до этого она лежала в холодильнике при температуре -18. Или лежала в сухом виде еще 10 лет. У нее всхожесть немного уменьшится, но незначительно, она все равно взойдет. Убить плесень, даже если вы пережарите хлеб, невозможно.
Потому что, если вы бросите сухари пережаренные в квас, квас будет бурлить. Это говорит о том, что как только она попадет в белково–углеводную среду, то начинает размножаться.
Всё, что является дрожжевым, для нас несет определенную плесневую опасность. Потому что виды плесени, они все содружественны, то есть это свой класс. И там, где живет одна плесень, может жить другая, третья.
Одна из самых патогенных плесеней для нас — это всё-таки кандида. Но есть более, гораздо более вредные плесени, такие как аспиргирус, черная плесень, мукурусумузус. Плесень — это слово объединяющее, на самом деле каждый грибок грибку рознь. Ногтевые грибки — это не то же самое, что кандида. Какие-то грибки поражают лимфатические узлы в паху, другие под грудью, третьи поражают ногтевую пластину и живут только на ногтях. Какие–то поражают только слизистые оболочки и живут во рту, в виде кандидозов и стоматитов или во влагалище в виде кандидозов и вагинитов. Какие-то грибки поражают кожные покровы и живут на коже в виде трещин, псориаза, экземы, нейродермита, но везде — это класс грибы. Как попадают грибы в организм? Г
рибы попадают в организм: - с испорченной пищей, — с водой, — с воздуха, — со старыми пыльными вещами. Очень верно сказано, что если абрикос или виноград с плесенью, то их есть нельзя. Но если в ящике есть плесень, то она есть на всех фруктах. Наш организм обладает хорошим фактором — это концентрация желудочного сока, который эту плесень подавляет, и, по идее, через желудочно–кишечный тракт она не должна проникать. Плесень может вторгаться к нам через кожу. Везде, где мы паримся, где мы ходим босиком, везде, где для неё есть условия, то есть влажность, температура, органические остатки (например, грязь или жир человека) — для плесени есть еда. Как проникает грибок между пальцами ног? Он через неповрежденную кожу не просочится, он к ней даже не магнитится. Но если в коже есть микротравмочки: царапинки, опрелости, повреждения кожного покрова, то грибок мгновенно туда цепляется. И стоит ему пройти кожный барьер, как он приживается.
Признаки гриба в организме человека
1. Всё, что зудит. Вот говорят: — У меня собака заболела. — Что с собакой? — Ухо простудила. — Что делает? — Чешет. Если собака чешет ухо, значит, у нее в ухе грибок. Если человек чешет ухо спичкой, зубочисткой, то здесь один вариант — грибок, других вариантов нет. Что-то у меня в ухе случилось, что-то там болит, что-то там течет, но если появился зуд — это грибок.
2. Трещины, пузыри, потертости (не мозоли, а образуются потертости непонятного характера, вроде бы ничего не стирали, например, в паховых складках — образуется что-то мокнущее). Везде, где шелушится, трескается и мокнет одновременно.
3. Часто приходят люди и показывают на ладонях, на тыльных сторонах, что-то непонятное, как — будто покарябано — обожжено. Всё, что на руках, под мышками, в паховых складках — это все грибы. Если откуда–то выделяется что-то белое, творожистое — то это тоже грибы. Неважно, изо рта ли, влагалища, или бронхов, миндалин.
4. Всё, что на языке белое, творожистое, крупинчатое — это все грибы.Вечером спать легли — язык был нормальный, утром встали — обложен белым налетом. Белый налет — это и есть грибок. Лимфатическая система всю ночь собирает этот белый налет на ворсиночках языка, как на ковриках у двери, откладывает, потому что дальше он идет на выброс. Слущивается с языка и вместе с питанием выплевывается, либо отхаркивается. Надо язык отскабливать палочкой, либо ложечкой. Налета на языке быть не должно. Язык должен быть розовым, с выраженными сосочками.
5. Всё, что не болит — это грибок. Потому что грибы перегрызают нервные окончания. К коже идёт огромное количество нервных окончаний. Что бы чувствовал больной псориазом, если огромные поверхности его кожи постоянно, ежесекундно бы раздражались, он бы просто с ума сошел от боли. Когда мы кнопкой уколем палец, боль такая, что мы подскакиваем. Если бы поверхности псориаза были бы болезненны, то это было бы сильное болевое перераздражение, и человек бы умер от болевого шока. Грибок целенаправленно с этим работает, он все откусывает, завоевывает кожу и делает ее управляемой. У него там свои замки, свои дворцы.
6. Всё, что на коже обсыпается, отпадает, возвышается, шелушится кольцами (равномерно, неравномерно), везде, где есть чешуйки. Как правило, грибок располагается в зоне крупных лимфатических узлов, по одной простой причине — грибок находится в межклеточном пространстве. Вот клетка, вот межклеточное пространство — вода, потенциал этой воды — 50 приблизительно.
Среда должна быть либо щелочная, либо кислая, вокруг клеток размножается грибок. Сюда он попадает с током крови с пищеварительного тракта в межклеточную воду. Межклеточная вода должна протекать, каждое утро сюда должна поступать вода и каждое утро она должна стравливаться и уходить.
Стравливается она через лимфатическую систему. Лимфатические протоки заканчиваются лимфатическими узлами. В лимфатических узлах отсеки, 10 входов, один выход. И здесь происходит обработка лимфоцитами тех жизненных молекулярных форм, которые засосались сюда и происходит очищение. Чистая лимфа идет в одну сторону, а грязная лимфа идет в другую, на выброс.
У человека заболел коленный сустав. Вот один мосел, вот другой мосел. Между ними хрящи. Что тут может болеть? Кости болеть не могут, хрящ тоже, там нет болевых окончаний. Между хрящами находится жидкость. Она тоже не болит, но она может быть воспалена, в ней может кто–то жить. Сзади за суставом, со стороны подколенной ямки, есть лимфоузлы. Если есть грибок на ногах, он будет подниматься вверх, к подколенным лимфоузлам. Лимфоузлы грибок задержат, и в этот момент они перестанут пропускать воду наверх. Сустав опухнет. А когда он будет опухать, то заболит.
Что сделает организм? Он поднимет температуру, чтобы усилить микроциркуляцию, чтобы в сустав пришли лейкоциты. Что сделает врач? Обезболит, назначит аспирин. Это поможет? Не поможет. Белагил поможет? Не поможет. Диклофенак поможет? Не поможет. Ультразвук поможет? Нет. Сначала нужно разобраться, что тут в суставе. Либо грибы, либо бактерии.
Если у человека все ногти на ногах в грибках, с трёх раз угадайте, что у него в суставе? Грибы. И никакие антибиотики здесь не помогут. Потому что лимфатическая система верхнего сегмента будет держать то же самое, что находится в нижнем сегменте, чтобы они не прошли дальше, иначе грибок завоюет все. Это кордон, это пограничная застава. Выше её никто не пройдет.
Если где-то кто–то поселился, то там развивается война. Война между лейкоцитами и тем, кто поселился. Тот, кто поселился, бывает 5 видов: вирусы, грибы, гельминты, простейшие, бактерии. Простейшие в суставах не живут. Тут не живут токсоплазмы, лямблии, аписторхи. Если в суставе кто–то поселился, заболевание будет оканчиваться на — ит. Бронхит, артрит, гайморит, гастрит, синусит, конъюктевит, стоматит, нефрит и так далее. Кто-то там живет, там идет война, инфекция. Инфекция бывает 5 видов Чтобы было понятно, гайморит, это у нас как? Какой–то гной в носу. Что за гной в носу, откуда он там взялся?
Нос — это дырка, просто дырка, и просто пазуха. Больше ничего нет, там никакого гноя быть не может. Он может подойти на "эскалаторе" лимфатической системы. Но подойдет он по своему пути. Почему он в нос идет? На выброс, выход наружу. Может пойти в бронхи, во влагалище, в кишечник.
С верхней части тела идет в нос, из половых путей в нос не пойдет. С половых путей он высадится на первом этаже лифта. Бесполезно бороться с белями и выделениями, с этим бороться не надо. Если они есть, это говорит о чем? Что есть грибок и что работает лимфатическая система. Когда вы его не трогали, а он сам по себе прошел, о чем это говорит? Что все нормально, что все справилось, если он самостоятельно прекратился.
Вот ваш желудок, а что вы, например, едите такого? Чеснок, или берете перец горький и 20 штук съели сразу, прямо горошины. И у вас остановится сразу весь понос. Эфирное масло грейпфрута, чайного дерева — все действует точно так же, как и сам продукт. Растение может у нас быть нескольких видов. Само растение, отвар растения, напар растения, эфирное масло растения, масло растения, листья растения, лапки растения, настойка растения.
Любая продукция, приготовленная из растения, будет действовать точно так же, как и само растение. Возьмете вы петрушку или сок из петрушки, сок из клюквы или саму клюкву, без разницы, все работает одинаково. Вот вы взяли масло кунжута, а кунжут сам по себе является сильным противопаразитарным средством. Масло кунжута вы добавляете в салат, оно очень вкусное, попробуйте черное масло кунжута, так плюс к этому оно является очень мощным антипаразитарным средством.
Вы просто кушаете салат, помидоры, огурцы, петрушка, тмин, укроп, сельдерей и добавляете масло кунжута, семена кунжута и у вас получается очень вкусный, противопаразитарный салат. Если каждый день будете употреблять что–то такое противопаразитарное, противогрибковое, то у вас не будет ни вирусов, ни бактерий, ни паразитов. Только в допустимых нормах, либо в минимальных концентрациях, чтобы вам не принесло никакого вреда. Посмотрим вокруг себя, внутрь себя.
Наша центральная нервная система настолько мощна, что может любой иммунитет послать в любое место, раскопать любую войну и прекратить ее. Но для этого нужно что? Энергия, целеустремленность, для этого нужны знания, нужна большая вера, для этого нужен правильный образ жизни, алгоритм, который нужно будет делать каждый день. Сказано, чеснок каждый день, значит чеснок каждый день. Не переносите чеснок, значит, хрен каждый день.
Хрен не переносите, значит, редьку каждый день. Найдите то, что вы переносите. 10 видов перца переносите, белый, красный, желтый, но это должно быть. Потому что грибок все завоюет, если вы даете ему каждый день макароны, на завтрак у него хлеб дрожжевой, на обед у него сгущенное молоко, на ужин у него картошка. Видели, как картошка плесенью покрывается? В три секунды. Попробуйте редиску плесенью покрыть. Замучаетесь.
Бывает иногда, когда в воздухе много спор или сметана рядом стояла. Вы видели когда–нибудь, чтоб растительное масло плесневело? Прогоркает, но плесневеет несильно. Потому что там грибкам делать нечего, там есть особые вещества. Растения, которые находятся в противоборстве с грибками. Они ненавидят гельминтов, почти все, у них есть разум и они находятся в противоборстве с гельминтами, вирусами, бактериями и со всеми остальными. Они за нас. За себя и за нас. Они выискивают средства, каждое растение выискивает что–то такое, чтобы его не съели. Кто не съел? Грибы, вирусы, бактерии, паразиты и мы.
Потому что мы тоже не всегда все правильно делаем, против нас тоже кое–что настроено, мы не можем все съесть, нам нельзя все съесть. Но вот если мы знаем, что растение уже настроилось, мы это растение можем использовать в свое благо. Это очень важно, понимать, что делают грибы в организме. Просто живут. Они питаются, размножаются, двигаются, перемещаются. А мы что делаем? Кормим, выращиваем, и постоянно добавляем, каждый Божий день. То мы пьем кефирный грибок, то мы пьем сопливый чайный гриб, то мы пьем кордецепс, то пиво пьем, то с утра до ночи едим дрожжевой хлеб, то еще дрожжи пить начинаем.
Противогрибковая еда Это чеснок, лук. Все, что является противопаразитарным, одновременно является и противогрибковым, но добавляется другое еще. Хвоя, пихта, сосна, ель. Вся живица сюда добавляется. Живица, это то, что течет, смола от ели, чтоб ее не съел грибок. Сосна законсервирована, то есть она не боится грибка, она живет не 30 лет, как береза. И поэтому кедр долго живет, вся хвойная порода.
Смолу можно класть в компоты, делать отвары, напар, можно настаивать на воде, можно кипятить и вдыхать пар. Лучше всего молодые лапки хвои сосны, пихты иметь засушенные, просто класть в чай, можно готовить любые напитки. Смолу можно жевать, добавлять в жвачку. Все, что обладает противогрибковым действием, обладает этим действием в маслах.
Масло кедрового ореха, оно тоже противогрибковое. Чайное дерево и все продукты из чайного дерева. Если идет тяжелая грибковая патология, то можно по одной капле масла чайного дерева разводить в 1 чайной ложке сметаны и съедать, потому что в воде оно не растворяется. Много не надо, это 1 капелька, взрослому человеку можно 2 капельки. Если это делать подряд 2 месяца, то с грибком можно будет серьезно поспорить и посоперничать.
Эфирное масло лучше растворять в жире. Это могут быть какие угодно жиры. Прополис. Можно пить настойку прополиса или водный отвар, или напар, или класть прополис в мед, или класть его в варенье, или просто его жевать, или кушать соты, можно кусок прополиса просто за щеку засунуть, пусть он там лежит и всасывается в слюну. Неважно, какими способами его туда доставить. Можно из него сделать настойку. Не хотите настойку — делайте водный напар. Не хотите напар, просто жуйте его как жвачку. Как он внутрь попадет, это уже другая история, главное, чтоб он туда попал.
Все то, что является антигельминтным, одновременно является (большинство) и противогрибковым. Это перец, все виды, это редька, это хрен, все приправы, начиная с зиры и заканчивая куркумой. Ногтевые грибки можно вылечить. Лечение нужно изнутри и снаружи. Только снаружи ногтевые грибки точно не вылечить. Изнутри отдельно тоже сложно. Но если с той и с другой стороны, то можно вылечить в течение даже полугода. Но опять же, нужно понимать механизм, грибки живут не на ногтях, а внутри суставной жидкости. От колена и до стопы вся лимфа заражена грибком.
Также интересно: Лечение грибка стопы содой. Причем стоит немедленно исключить дрожжи из своего рациона. Что еще действует на грибки Всё, что является кисло–органическим. Это смородина, крыжовник, калина, рябина, брусника, клюква, облепиха, черника, ежевика, голубика — все кислые ягоды, они являются противогрибковыми…
Автор: Ольга Бутакова
Грибы — это другая цивилизация, при этом самая древняя, практически вечная субстанция. Вытравить грибы из организма человека очень-очень сложно. Если грибок уже заселился, и, условно говоря, развил свою грибницу, то возникают достаточно сложные проблемы.
Грибы бывают разные. Бывают, якобы благородные грибы, бывают низшие грибы (называются плесень). У грибов очень много марок, очень много названий, более 50 видов. Есть грибы малотоксичные, есть грибы лесные, есть низшие, есть высшие.
Высших грибов целый класс — это китайский кордицепс, рейкет. В чем заключается смысл гриба? Смысл заключается в том, что у него есть генетический код и это не единичная особь, а особь, которая живет колониями. При чем, между этими колониями существует точная взаимосвязь сегментов. То есть каждый грибной элемент связан с другими грибными элементами тысячами сегментных связей.
Если мы хотим, чтобы наш организм был свободен от грибов, единственное, что мы можем, это не давать ему пищу. Потому что, если в нашем организме достаточно пищи для грибов, то они в нем будут. Вот, например, в хлебнице лежит хлеб. На нем образовалась плесень. Если вы хлеб уберете и оставите плесень, то постепенно эта плесень погибнет.
Потому что ей нечего будет кушать. Она высохнет, не размножится, потому что для размножения ей нужны питательные вещества. Питается плесень в основном белковыми продуктами, потому что ей нужны аминокислоты.
Вот, например, мы берем муку, добавляем сахар, масло — энергию, добавляем воду, добавляем дрожжи — это вот и есть плесень особого рода — хлебная плесень.
Дальше мы этой плесени даем температуру, обязательно 37, потом даем ей особую влажность и кислород. И тогда она начинает размножаться, реанимироваться. Причем, до этого она лежала в холодильнике при температуре -18. Или лежала в сухом виде еще 10 лет. У нее всхожесть немного уменьшится, но незначительно, она все равно взойдет. Убить плесень, даже если вы пережарите хлеб, невозможно.
Потому что, если вы бросите сухари пережаренные в квас, квас будет бурлить. Это говорит о том, что как только она попадет в белково–углеводную среду, то начинает размножаться.
Всё, что является дрожжевым, для нас несет определенную плесневую опасность. Потому что виды плесени, они все содружественны, то есть это свой класс. И там, где живет одна плесень, может жить другая, третья.
Одна из самых патогенных плесеней для нас — это всё-таки кандида. Но есть более, гораздо более вредные плесени, такие как аспиргирус, черная плесень, мукурусумузус. Плесень — это слово объединяющее, на самом деле каждый грибок грибку рознь. Ногтевые грибки — это не то же самое, что кандида. Какие-то грибки поражают лимфатические узлы в паху, другие под грудью, третьи поражают ногтевую пластину и живут только на ногтях. Какие–то поражают только слизистые оболочки и живут во рту, в виде кандидозов и стоматитов или во влагалище в виде кандидозов и вагинитов. Какие-то грибки поражают кожные покровы и живут на коже в виде трещин, псориаза, экземы, нейродермита, но везде — это класс грибы. Как попадают грибы в организм? Г
рибы попадают в организм: - с испорченной пищей, — с водой, — с воздуха, — со старыми пыльными вещами. Очень верно сказано, что если абрикос или виноград с плесенью, то их есть нельзя. Но если в ящике есть плесень, то она есть на всех фруктах. Наш организм обладает хорошим фактором — это концентрация желудочного сока, который эту плесень подавляет, и, по идее, через желудочно–кишечный тракт она не должна проникать. Плесень может вторгаться к нам через кожу. Везде, где мы паримся, где мы ходим босиком, везде, где для неё есть условия, то есть влажность, температура, органические остатки (например, грязь или жир человека) — для плесени есть еда. Как проникает грибок между пальцами ног? Он через неповрежденную кожу не просочится, он к ней даже не магнитится. Но если в коже есть микротравмочки: царапинки, опрелости, повреждения кожного покрова, то грибок мгновенно туда цепляется. И стоит ему пройти кожный барьер, как он приживается.
Признаки гриба в организме человека
1. Всё, что зудит. Вот говорят: — У меня собака заболела. — Что с собакой? — Ухо простудила. — Что делает? — Чешет. Если собака чешет ухо, значит, у нее в ухе грибок. Если человек чешет ухо спичкой, зубочисткой, то здесь один вариант — грибок, других вариантов нет. Что-то у меня в ухе случилось, что-то там болит, что-то там течет, но если появился зуд — это грибок.
2. Трещины, пузыри, потертости (не мозоли, а образуются потертости непонятного характера, вроде бы ничего не стирали, например, в паховых складках — образуется что-то мокнущее). Везде, где шелушится, трескается и мокнет одновременно.
3. Часто приходят люди и показывают на ладонях, на тыльных сторонах, что-то непонятное, как — будто покарябано — обожжено. Всё, что на руках, под мышками, в паховых складках — это все грибы. Если откуда–то выделяется что-то белое, творожистое — то это тоже грибы. Неважно, изо рта ли, влагалища, или бронхов, миндалин.
4. Всё, что на языке белое, творожистое, крупинчатое — это все грибы.Вечером спать легли — язык был нормальный, утром встали — обложен белым налетом. Белый налет — это и есть грибок. Лимфатическая система всю ночь собирает этот белый налет на ворсиночках языка, как на ковриках у двери, откладывает, потому что дальше он идет на выброс. Слущивается с языка и вместе с питанием выплевывается, либо отхаркивается. Надо язык отскабливать палочкой, либо ложечкой. Налета на языке быть не должно. Язык должен быть розовым, с выраженными сосочками.
5. Всё, что не болит — это грибок. Потому что грибы перегрызают нервные окончания. К коже идёт огромное количество нервных окончаний. Что бы чувствовал больной псориазом, если огромные поверхности его кожи постоянно, ежесекундно бы раздражались, он бы просто с ума сошел от боли. Когда мы кнопкой уколем палец, боль такая, что мы подскакиваем. Если бы поверхности псориаза были бы болезненны, то это было бы сильное болевое перераздражение, и человек бы умер от болевого шока. Грибок целенаправленно с этим работает, он все откусывает, завоевывает кожу и делает ее управляемой. У него там свои замки, свои дворцы.
6. Всё, что на коже обсыпается, отпадает, возвышается, шелушится кольцами (равномерно, неравномерно), везде, где есть чешуйки. Как правило, грибок располагается в зоне крупных лимфатических узлов, по одной простой причине — грибок находится в межклеточном пространстве. Вот клетка, вот межклеточное пространство — вода, потенциал этой воды — 50 приблизительно.
Среда должна быть либо щелочная, либо кислая, вокруг клеток размножается грибок. Сюда он попадает с током крови с пищеварительного тракта в межклеточную воду. Межклеточная вода должна протекать, каждое утро сюда должна поступать вода и каждое утро она должна стравливаться и уходить.
Стравливается она через лимфатическую систему. Лимфатические протоки заканчиваются лимфатическими узлами. В лимфатических узлах отсеки, 10 входов, один выход. И здесь происходит обработка лимфоцитами тех жизненных молекулярных форм, которые засосались сюда и происходит очищение. Чистая лимфа идет в одну сторону, а грязная лимфа идет в другую, на выброс.
У человека заболел коленный сустав. Вот один мосел, вот другой мосел. Между ними хрящи. Что тут может болеть? Кости болеть не могут, хрящ тоже, там нет болевых окончаний. Между хрящами находится жидкость. Она тоже не болит, но она может быть воспалена, в ней может кто–то жить. Сзади за суставом, со стороны подколенной ямки, есть лимфоузлы. Если есть грибок на ногах, он будет подниматься вверх, к подколенным лимфоузлам. Лимфоузлы грибок задержат, и в этот момент они перестанут пропускать воду наверх. Сустав опухнет. А когда он будет опухать, то заболит.
Что сделает организм? Он поднимет температуру, чтобы усилить микроциркуляцию, чтобы в сустав пришли лейкоциты. Что сделает врач? Обезболит, назначит аспирин. Это поможет? Не поможет. Белагил поможет? Не поможет. Диклофенак поможет? Не поможет. Ультразвук поможет? Нет. Сначала нужно разобраться, что тут в суставе. Либо грибы, либо бактерии.
Если у человека все ногти на ногах в грибках, с трёх раз угадайте, что у него в суставе? Грибы. И никакие антибиотики здесь не помогут. Потому что лимфатическая система верхнего сегмента будет держать то же самое, что находится в нижнем сегменте, чтобы они не прошли дальше, иначе грибок завоюет все. Это кордон, это пограничная застава. Выше её никто не пройдет.
Если где-то кто–то поселился, то там развивается война. Война между лейкоцитами и тем, кто поселился. Тот, кто поселился, бывает 5 видов: вирусы, грибы, гельминты, простейшие, бактерии. Простейшие в суставах не живут. Тут не живут токсоплазмы, лямблии, аписторхи. Если в суставе кто–то поселился, заболевание будет оканчиваться на — ит. Бронхит, артрит, гайморит, гастрит, синусит, конъюктевит, стоматит, нефрит и так далее. Кто-то там живет, там идет война, инфекция. Инфекция бывает 5 видов Чтобы было понятно, гайморит, это у нас как? Какой–то гной в носу. Что за гной в носу, откуда он там взялся?
Нос — это дырка, просто дырка, и просто пазуха. Больше ничего нет, там никакого гноя быть не может. Он может подойти на "эскалаторе" лимфатической системы. Но подойдет он по своему пути. Почему он в нос идет? На выброс, выход наружу. Может пойти в бронхи, во влагалище, в кишечник.
С верхней части тела идет в нос, из половых путей в нос не пойдет. С половых путей он высадится на первом этаже лифта. Бесполезно бороться с белями и выделениями, с этим бороться не надо. Если они есть, это говорит о чем? Что есть грибок и что работает лимфатическая система. Когда вы его не трогали, а он сам по себе прошел, о чем это говорит? Что все нормально, что все справилось, если он самостоятельно прекратился.
Вот ваш желудок, а что вы, например, едите такого? Чеснок, или берете перец горький и 20 штук съели сразу, прямо горошины. И у вас остановится сразу весь понос. Эфирное масло грейпфрута, чайного дерева — все действует точно так же, как и сам продукт. Растение может у нас быть нескольких видов. Само растение, отвар растения, напар растения, эфирное масло растения, масло растения, листья растения, лапки растения, настойка растения.
Любая продукция, приготовленная из растения, будет действовать точно так же, как и само растение. Возьмете вы петрушку или сок из петрушки, сок из клюквы или саму клюкву, без разницы, все работает одинаково. Вот вы взяли масло кунжута, а кунжут сам по себе является сильным противопаразитарным средством. Масло кунжута вы добавляете в салат, оно очень вкусное, попробуйте черное масло кунжута, так плюс к этому оно является очень мощным антипаразитарным средством.
Вы просто кушаете салат, помидоры, огурцы, петрушка, тмин, укроп, сельдерей и добавляете масло кунжута, семена кунжута и у вас получается очень вкусный, противопаразитарный салат. Если каждый день будете употреблять что–то такое противопаразитарное, противогрибковое, то у вас не будет ни вирусов, ни бактерий, ни паразитов. Только в допустимых нормах, либо в минимальных концентрациях, чтобы вам не принесло никакого вреда. Посмотрим вокруг себя, внутрь себя.
Наша центральная нервная система настолько мощна, что может любой иммунитет послать в любое место, раскопать любую войну и прекратить ее. Но для этого нужно что? Энергия, целеустремленность, для этого нужны знания, нужна большая вера, для этого нужен правильный образ жизни, алгоритм, который нужно будет делать каждый день. Сказано, чеснок каждый день, значит чеснок каждый день. Не переносите чеснок, значит, хрен каждый день.
Хрен не переносите, значит, редьку каждый день. Найдите то, что вы переносите. 10 видов перца переносите, белый, красный, желтый, но это должно быть. Потому что грибок все завоюет, если вы даете ему каждый день макароны, на завтрак у него хлеб дрожжевой, на обед у него сгущенное молоко, на ужин у него картошка. Видели, как картошка плесенью покрывается? В три секунды. Попробуйте редиску плесенью покрыть. Замучаетесь.
Бывает иногда, когда в воздухе много спор или сметана рядом стояла. Вы видели когда–нибудь, чтоб растительное масло плесневело? Прогоркает, но плесневеет несильно. Потому что там грибкам делать нечего, там есть особые вещества. Растения, которые находятся в противоборстве с грибками. Они ненавидят гельминтов, почти все, у них есть разум и они находятся в противоборстве с гельминтами, вирусами, бактериями и со всеми остальными. Они за нас. За себя и за нас. Они выискивают средства, каждое растение выискивает что–то такое, чтобы его не съели. Кто не съел? Грибы, вирусы, бактерии, паразиты и мы.
Потому что мы тоже не всегда все правильно делаем, против нас тоже кое–что настроено, мы не можем все съесть, нам нельзя все съесть. Но вот если мы знаем, что растение уже настроилось, мы это растение можем использовать в свое благо. Это очень важно, понимать, что делают грибы в организме. Просто живут. Они питаются, размножаются, двигаются, перемещаются. А мы что делаем? Кормим, выращиваем, и постоянно добавляем, каждый Божий день. То мы пьем кефирный грибок, то мы пьем сопливый чайный гриб, то мы пьем кордецепс, то пиво пьем, то с утра до ночи едим дрожжевой хлеб, то еще дрожжи пить начинаем.
Противогрибковая еда Это чеснок, лук. Все, что является противопаразитарным, одновременно является и противогрибковым, но добавляется другое еще. Хвоя, пихта, сосна, ель. Вся живица сюда добавляется. Живица, это то, что течет, смола от ели, чтоб ее не съел грибок. Сосна законсервирована, то есть она не боится грибка, она живет не 30 лет, как береза. И поэтому кедр долго живет, вся хвойная порода.
Смолу можно класть в компоты, делать отвары, напар, можно настаивать на воде, можно кипятить и вдыхать пар. Лучше всего молодые лапки хвои сосны, пихты иметь засушенные, просто класть в чай, можно готовить любые напитки. Смолу можно жевать, добавлять в жвачку. Все, что обладает противогрибковым действием, обладает этим действием в маслах.
Масло кедрового ореха, оно тоже противогрибковое. Чайное дерево и все продукты из чайного дерева. Если идет тяжелая грибковая патология, то можно по одной капле масла чайного дерева разводить в 1 чайной ложке сметаны и съедать, потому что в воде оно не растворяется. Много не надо, это 1 капелька, взрослому человеку можно 2 капельки. Если это делать подряд 2 месяца, то с грибком можно будет серьезно поспорить и посоперничать.
Эфирное масло лучше растворять в жире. Это могут быть какие угодно жиры. Прополис. Можно пить настойку прополиса или водный отвар, или напар, или класть прополис в мед, или класть его в варенье, или просто его жевать, или кушать соты, можно кусок прополиса просто за щеку засунуть, пусть он там лежит и всасывается в слюну. Неважно, какими способами его туда доставить. Можно из него сделать настойку. Не хотите настойку — делайте водный напар. Не хотите напар, просто жуйте его как жвачку. Как он внутрь попадет, это уже другая история, главное, чтоб он туда попал.
Все то, что является антигельминтным, одновременно является (большинство) и противогрибковым. Это перец, все виды, это редька, это хрен, все приправы, начиная с зиры и заканчивая куркумой. Ногтевые грибки можно вылечить. Лечение нужно изнутри и снаружи. Только снаружи ногтевые грибки точно не вылечить. Изнутри отдельно тоже сложно. Но если с той и с другой стороны, то можно вылечить в течение даже полугода. Но опять же, нужно понимать механизм, грибки живут не на ногтях, а внутри суставной жидкости. От колена и до стопы вся лимфа заражена грибком.
Также интересно: Лечение грибка стопы содой. Причем стоит немедленно исключить дрожжи из своего рациона. Что еще действует на грибки Всё, что является кисло–органическим. Это смородина, крыжовник, калина, рябина, брусника, клюква, облепиха, черника, ежевика, голубика — все кислые ягоды, они являются противогрибковыми…
Автор: Ольга Бутакова
Гринпис обнародовал чёрный список производителей...
2 лет назад от Сыроедение - Я ФРУКТОРИАНЕЦ
Гринпис обнародовал чёрный список производителей ГМ-продуктов
(По данным Greenpeace)
1 Шоколадные изделия Hershey's Cadbury Fruit&Nut
2 Mars M&M
3 Snickers
4 Twix
5 Milky Way
6 Cadbury (Кэдбери) шоколад, какао
7 Ferrero
8 Nestle шоколад "Нестле", "Россия"
9 Шоколадный напиток Nestle Nesquik
10 Безалкогольный напиток Соса-Соla "Кока-Кола" Соса-Соla
11 "Спрайт", "Фанта", тоник "Кинли", "Фруктайм"
12 Pepci-Со Pepsi
13 "7-Up", "Фиеста", "Маунтин Дью"
14 Сухие завтраки Kellogg's
15 Супы Campbell
16 Рис Uncle Bens Mars
17 Соусы Knorr
18 Чай Lipton
19 Печенье Parmalat
20 Приправы, майонезы, соусы Hellman's
21 Приправы, майонезы, соусы Heinz
22 Детское питание Nestle
23 Hipp
24 Abbot Labs Similac
25 Йогурты, кефир, сыр, детское питание Denon
26 McDonald's (Макдональдс) сеть "ресторанов" быстрого питания
27 шоколад, чипсы, кофе, детское питание Kraft (Крафт)
28 кетчупы, соусы. Heinz Foods (Хайенц Фудс)
29 детское питание, продукты "Делми" Unilever (Юнилевер)
Обратите внимание сколько продуктов для детей. Сохраните на стену, не потеряйте. Расскажите друзьям!
(По данным Greenpeace)
1 Шоколадные изделия Hershey's Cadbury Fruit&Nut
2 Mars M&M
3 Snickers
4 Twix
5 Milky Way
6 Cadbury (Кэдбери) шоколад, какао
7 Ferrero
8 Nestle шоколад "Нестле", "Россия"
9 Шоколадный напиток Nestle Nesquik
10 Безалкогольный напиток Соса-Соla "Кока-Кола" Соса-Соla
11 "Спрайт", "Фанта", тоник "Кинли", "Фруктайм"
12 Pepci-Со Pepsi
13 "7-Up", "Фиеста", "Маунтин Дью"
14 Сухие завтраки Kellogg's
15 Супы Campbell
16 Рис Uncle Bens Mars
17 Соусы Knorr
18 Чай Lipton
19 Печенье Parmalat
20 Приправы, майонезы, соусы Hellman's
21 Приправы, майонезы, соусы Heinz
22 Детское питание Nestle
23 Hipp
24 Abbot Labs Similac
25 Йогурты, кефир, сыр, детское питание Denon
26 McDonald's (Макдональдс) сеть "ресторанов" быстрого питания
27 шоколад, чипсы, кофе, детское питание Kraft (Крафт)
28 кетчупы, соусы. Heinz Foods (Хайенц Фудс)
29 детское питание, продукты "Делми" Unilever (Юнилевер)
Обратите внимание сколько продуктов для детей. Сохраните на стену, не потеряйте. Расскажите друзьям!

СОВЕТЫ ПО ПРАВИЛЬНОМУ ГОЛОДАНИЮОТ АРНОЛЬДА...
2 лет назад от Сыроедение - Я ФРУКТОРИАНЕЦ
СОВЕТЫ ПО ПРАВИЛЬНОМУ ГОЛОДАНИЮ
ОТ АРНОЛЬДА ЭРЕТА
Голодание, под которым я подразумеваю жизнь без твердой и жидкой пищи, - до сих пор в полной мере не считается средством исцеления. Некоторые обыватели фактически будут считать вас неразумным, если вы пропустите несколько приемов пищи во время болезни. Они думают, что этим вы истощаете себя. Такие люди фактически не в состоянии понять разницу между голоданием и истощением. Причина того, почему много голоданий были неудачными и продолжают такими быть, - невежество. Когда вы начинаете голодать, то первыми удаляются основные отходы, созданные неправильным и чрезмерным питанием. Некоторое время вы можете чувствовать себя относительно хорошо, возможно, даже лучше, чем во время принятия пищи. Но со временем новое, вторичное, мусор в организме заполняет собой кровообращение, и из-за этого самочувствие ухудшается. Вы начинаете обвинять в этом недостаток пищи. Тем не менее, когда большая часть мусора из кровообращения будет устранена, вы будете чувствовать себя чудесно - еще более сильным, чем раньше. Однако два или три дня спустя этот процесс повторяется. Так будет продолжаться, пока организм полностью не очистится. Известен факт, что голодающий чувствует себя лучше на 20-е сутки голодания, чем на 5 или 6-е. Это доказательство того, что живучесть зависит не от пищи, а, скорее всего, от свободного, беспрепятственного кровообращения. Однако продолжительное голодание (20 и свыше 21 суток) может существенно навредить вам.
ДВА ШАГА К ГОЛОДАНИЮ
Как подготовку к голоданию можно считать отказ от завтрака. Наиболее плохой в питании является привычка наполнять желудок пищей утром. В европейских странах, за исключением Британии, никто не потребляет тяжелой пищи на завтрак. Обычно он состоит из какого-то напитка и хлеба. Единственное время, когда человек не ест на протяжении 10-12 часов, - это ночью, когда он спит. Как только его желудок освобождается от пищи, тело начинает процесс элиминации (выделение и выведение шлаков). Поэтому полные люди, просыпаясь утром, чувствуют себя несчастными и, как правило, имеют очень обложенный язык. И хотя у них нет аппетита, они все же едят, чувствуя после этого улучшение. Почему? Как только вы наполняете желудок пищей - элиминация прекращается и самочувствие улучшается. Чем больше мусора накопил человек в теле, тем больше он должен есть, чтобы остановить элиминацию. У меня были пациенты, которые должны были есть несколько раз за ночь, чтобы заснуть. Другими словами, они должны были наполнить свой желудок пищей, во избежание введения в циркуляцию накопленных там слизи и ядов. Следующим шагом к голоданию будет 24-часовое пребывание без пищи. Как и в случае отказа от завтрака, с помощью 24-часового голодания можно избавиться от легких заболеваний. Потом постепенно нужно переходить к 3, 4 или 5-дневным голоданиям, употребляя между ними бесслизистую пищу 1, 2, 3 или 4 дня. Этот режим позволит индивидуально регулировать элиминацию и одновременно непрерывно будет снабжать тело восстановительными элементами, содержащимися только в бесслизистых продуктах. Благодаря таким периодическим голоданиям, кровь постепенно улучшится и восстановится.
ПРОДОЛЖИТЕЛЬНОСТЬ ГОЛОДАНИЯ ОПРЕДЕЛЯЕТСЯ ИНДИВИДУАЛЬНО
Четко сказать, сколько времени нужно голодать, невозможно. Это определяется очень индивидуально с помощью тщательного наблюдения за тем, как изменяется состояние организма. Кроме того, голодание нужно немедленно прервать, как только заметите, что препятствия в кровообращении становятся слишком большими и кровь нуждается в новых жизненных веществах, чтобы нейтрализовать яды. Не следует думать: «чем продолжительнее голодание, тем лучше исцеление!» Теперь вы можете четко понять, почему это не так. Совет «экспертов» голодать до тех пор, пока язык не очистится, обусловливает много неприятностей у «фанатиков» голодания. Чтобы голодание проходило с наименьшими проблемами, нужно: - подготовиться к нему, постепенно заменяя диету бесслизистой и применяя слабительные средства и клизмы; - за несколько дней до начала более продолжительного голодания принимать иногда слабительные средства и обязательно - за день до начала; - чередовать короткие голодания с несколькими днями употребления очистительной и бедной слизью пищей; - быть особенно осторожным тем, кто принимал много лекарств, в частности, если в их составе были ртуть, селитра, окись серебра. В этом случае желательно продолжительное, медленное и постепенное изменение диеты.
Во время голодания нужно: - очищать каждый день толстую кишку клизмами; - как можно больше быть на свежем воздухе; - заниматься физкультурой или как-то иначе нагружать себя физически. Но если чувствуете себя уставшими и слабыми - отдыхайте и спите столько, сколько можете себе позволить. В такие дни (а это вероятно, когда отходы попадут в кровообращение) сон становится неспокойным и нарушается, даже могут сниться ужасы. Это обусловлено ядами, которые проходят через мозг. Могут появиться сомнения, разочарование в том, что вы делаете. Если возникли такие состояния и ощущения, то это происходит из-за лекарств, которые вы раньше употребляли: они перешли теперь в кровообращение для дальнейшего выведения из организма. Рекомендуется сразу сделать клизму и лечь, а при необходимости прервать голодание, но не фруктами; - каждый раз, изменяя положение тела, делайте это медленно, иначе может случиться умопомрачение, вплоть до кратковременной потери сознания. Последнего не стоит бояться, но нужно избегать. Много голодающих и людей на жестко ограниченной диете после умопомрачения сдавались и перерывали процесс голодания, утратив веру в него навсегда.
ЧТО И СКОЛЬКО ПИТЬ
Некоторые голодающие пьют только воду. Я считаю, что легкий лимонад с небольшим количеством меда или неочищенного сахара или очень разбавленный фруктовый сок дают лучший эффект. Тем не менее, нужно быть чрезвычайно осторожным, если сок фруктовый, например апельсиновый, используется при более продолжительном голодании, поскольку фруктовые соки могут сильно раздражать органы и вносит диссонанс в их работу. Как альтернативу хорошо пить соки, приготовленные из некрахмалистых овощей, в частности, их хорошо употреблять при более продолжительном голодании. Сырой томатный сок также можно пить. Относительно частоты и количества употребления жидкости, то пить нужно не чаще, чем обычно, и не более 2-3 л в день. Тем не менее имейте в виду: чем меньше жидкости вы пьете, тем агрессивнее действует голодание.
КАК ВЫХОДИТЬ ИЗ ГОЛОДАНИЯ
Правильное питание после голодания так же важно, как и само голодание. В то же время оно полностью зависит от самочувствия человека и продолжительности голодания.
ВАЖНЫЕ ПРАВИЛА, КОТОРЫЕ НУЖНО ХОРОШО ЗАПОМНИТЬ!
1. На протяжении нескольких дней после голодания первая пища должна иметь слабительный эффект, а не питательную ценность, как думает большинство людей.
2. Чем быстрее первая пища переварится, тем эффективнее она выведет ослабленную слизь и яды из кишечника и желудка.
3. Если после 2-3 часов после еды нет обильного испражнения, нужно помочь себе слабительным и клизмами. Каждый раз, когда я постился, я всегда имел хорошее испражнение, по крайней мере, через один час после еды. И чувствовал себя чудесно. После прерывания продолжительного голодания следующую ночь я проводил больше времени в туалете, чем в кровати, - так и должно быть.
4. Чем продолжительнее было голодание, тем эффективнее работает кишечник после того, как оно завершено.
5. Лучшие слабительные продукты, которые рекомендуется употреблять после голодания, - это всяческие свежие сладкие фрукты: вишни, виноград, яблоки и др. На втором месте - квашеные или тушеные сливы. Внимание! Это совет только для людей, которые определенное время жили на бесслизистых или на обедненных слизью продуктах, т.е. на «диете перехода».
6. Если первая пища не создает неприятностей, вы можете есть столько, сколько захотите. Потребление очень маленького количества пищи на протяжении первых 2 или 3 дней без испражнений, что является следствием недостаточного питания, опасно. Это еще один неправильный совет «экспертов»!
7. Если вы поели фруктов, но через час после этого не ощущаете движения в кишечнике, то съешьте еще фруктов или сырых или приготовленных (вареные, тушеные, но не жареные) некрахмалистых овощей. Ешьте до тех пор, пока с первым испражнением не выйдет мусор, накопленный во время голодания. Организм, свободный от всех отходов и ядов, при условии, когда никакие твердые продукты не употребляются внутрь, функционирует без препятствий. Если "база" Вашей крови сформирована из элементов продуктов, которые я преподаю, то Ваш мозг будет функционировать удивительным для Вас образом. Ваша прежняя жизнь будет казаться сном, и впервые в Вашем существовании, сознание пробудится до уровня "реального самосознания".Ваш ум, Ваши размышления, Ваши идеалы и стремления, Ваша философия изменятся основательно и таким способом который слов не хватит описать.Ваша душа будет кричать от радости и одерживать победу над всем страданием жизни, оставляя его позади Вас. Впервые Вы будете чувствовать восхитительно сотрясающую вибрацию жизненной силы, проходящую через Ваше тело (как слабый электрический ток).Вы изучите и поймете, что голодание и Высшее голодание (а не тома по психологии и философии) — единственный и реальный ключ к Высшей жизни — к обретению духовного мира.
ОТ АРНОЛЬДА ЭРЕТА
Голодание, под которым я подразумеваю жизнь без твердой и жидкой пищи, - до сих пор в полной мере не считается средством исцеления. Некоторые обыватели фактически будут считать вас неразумным, если вы пропустите несколько приемов пищи во время болезни. Они думают, что этим вы истощаете себя. Такие люди фактически не в состоянии понять разницу между голоданием и истощением. Причина того, почему много голоданий были неудачными и продолжают такими быть, - невежество. Когда вы начинаете голодать, то первыми удаляются основные отходы, созданные неправильным и чрезмерным питанием. Некоторое время вы можете чувствовать себя относительно хорошо, возможно, даже лучше, чем во время принятия пищи. Но со временем новое, вторичное, мусор в организме заполняет собой кровообращение, и из-за этого самочувствие ухудшается. Вы начинаете обвинять в этом недостаток пищи. Тем не менее, когда большая часть мусора из кровообращения будет устранена, вы будете чувствовать себя чудесно - еще более сильным, чем раньше. Однако два или три дня спустя этот процесс повторяется. Так будет продолжаться, пока организм полностью не очистится. Известен факт, что голодающий чувствует себя лучше на 20-е сутки голодания, чем на 5 или 6-е. Это доказательство того, что живучесть зависит не от пищи, а, скорее всего, от свободного, беспрепятственного кровообращения. Однако продолжительное голодание (20 и свыше 21 суток) может существенно навредить вам.
ДВА ШАГА К ГОЛОДАНИЮ
Как подготовку к голоданию можно считать отказ от завтрака. Наиболее плохой в питании является привычка наполнять желудок пищей утром. В европейских странах, за исключением Британии, никто не потребляет тяжелой пищи на завтрак. Обычно он состоит из какого-то напитка и хлеба. Единственное время, когда человек не ест на протяжении 10-12 часов, - это ночью, когда он спит. Как только его желудок освобождается от пищи, тело начинает процесс элиминации (выделение и выведение шлаков). Поэтому полные люди, просыпаясь утром, чувствуют себя несчастными и, как правило, имеют очень обложенный язык. И хотя у них нет аппетита, они все же едят, чувствуя после этого улучшение. Почему? Как только вы наполняете желудок пищей - элиминация прекращается и самочувствие улучшается. Чем больше мусора накопил человек в теле, тем больше он должен есть, чтобы остановить элиминацию. У меня были пациенты, которые должны были есть несколько раз за ночь, чтобы заснуть. Другими словами, они должны были наполнить свой желудок пищей, во избежание введения в циркуляцию накопленных там слизи и ядов. Следующим шагом к голоданию будет 24-часовое пребывание без пищи. Как и в случае отказа от завтрака, с помощью 24-часового голодания можно избавиться от легких заболеваний. Потом постепенно нужно переходить к 3, 4 или 5-дневным голоданиям, употребляя между ними бесслизистую пищу 1, 2, 3 или 4 дня. Этот режим позволит индивидуально регулировать элиминацию и одновременно непрерывно будет снабжать тело восстановительными элементами, содержащимися только в бесслизистых продуктах. Благодаря таким периодическим голоданиям, кровь постепенно улучшится и восстановится.
ПРОДОЛЖИТЕЛЬНОСТЬ ГОЛОДАНИЯ ОПРЕДЕЛЯЕТСЯ ИНДИВИДУАЛЬНО
Четко сказать, сколько времени нужно голодать, невозможно. Это определяется очень индивидуально с помощью тщательного наблюдения за тем, как изменяется состояние организма. Кроме того, голодание нужно немедленно прервать, как только заметите, что препятствия в кровообращении становятся слишком большими и кровь нуждается в новых жизненных веществах, чтобы нейтрализовать яды. Не следует думать: «чем продолжительнее голодание, тем лучше исцеление!» Теперь вы можете четко понять, почему это не так. Совет «экспертов» голодать до тех пор, пока язык не очистится, обусловливает много неприятностей у «фанатиков» голодания. Чтобы голодание проходило с наименьшими проблемами, нужно: - подготовиться к нему, постепенно заменяя диету бесслизистой и применяя слабительные средства и клизмы; - за несколько дней до начала более продолжительного голодания принимать иногда слабительные средства и обязательно - за день до начала; - чередовать короткие голодания с несколькими днями употребления очистительной и бедной слизью пищей; - быть особенно осторожным тем, кто принимал много лекарств, в частности, если в их составе были ртуть, селитра, окись серебра. В этом случае желательно продолжительное, медленное и постепенное изменение диеты.
Во время голодания нужно: - очищать каждый день толстую кишку клизмами; - как можно больше быть на свежем воздухе; - заниматься физкультурой или как-то иначе нагружать себя физически. Но если чувствуете себя уставшими и слабыми - отдыхайте и спите столько, сколько можете себе позволить. В такие дни (а это вероятно, когда отходы попадут в кровообращение) сон становится неспокойным и нарушается, даже могут сниться ужасы. Это обусловлено ядами, которые проходят через мозг. Могут появиться сомнения, разочарование в том, что вы делаете. Если возникли такие состояния и ощущения, то это происходит из-за лекарств, которые вы раньше употребляли: они перешли теперь в кровообращение для дальнейшего выведения из организма. Рекомендуется сразу сделать клизму и лечь, а при необходимости прервать голодание, но не фруктами; - каждый раз, изменяя положение тела, делайте это медленно, иначе может случиться умопомрачение, вплоть до кратковременной потери сознания. Последнего не стоит бояться, но нужно избегать. Много голодающих и людей на жестко ограниченной диете после умопомрачения сдавались и перерывали процесс голодания, утратив веру в него навсегда.
ЧТО И СКОЛЬКО ПИТЬ
Некоторые голодающие пьют только воду. Я считаю, что легкий лимонад с небольшим количеством меда или неочищенного сахара или очень разбавленный фруктовый сок дают лучший эффект. Тем не менее, нужно быть чрезвычайно осторожным, если сок фруктовый, например апельсиновый, используется при более продолжительном голодании, поскольку фруктовые соки могут сильно раздражать органы и вносит диссонанс в их работу. Как альтернативу хорошо пить соки, приготовленные из некрахмалистых овощей, в частности, их хорошо употреблять при более продолжительном голодании. Сырой томатный сок также можно пить. Относительно частоты и количества употребления жидкости, то пить нужно не чаще, чем обычно, и не более 2-3 л в день. Тем не менее имейте в виду: чем меньше жидкости вы пьете, тем агрессивнее действует голодание.
КАК ВЫХОДИТЬ ИЗ ГОЛОДАНИЯ
Правильное питание после голодания так же важно, как и само голодание. В то же время оно полностью зависит от самочувствия человека и продолжительности голодания.
ВАЖНЫЕ ПРАВИЛА, КОТОРЫЕ НУЖНО ХОРОШО ЗАПОМНИТЬ!
1. На протяжении нескольких дней после голодания первая пища должна иметь слабительный эффект, а не питательную ценность, как думает большинство людей.
2. Чем быстрее первая пища переварится, тем эффективнее она выведет ослабленную слизь и яды из кишечника и желудка.
3. Если после 2-3 часов после еды нет обильного испражнения, нужно помочь себе слабительным и клизмами. Каждый раз, когда я постился, я всегда имел хорошее испражнение, по крайней мере, через один час после еды. И чувствовал себя чудесно. После прерывания продолжительного голодания следующую ночь я проводил больше времени в туалете, чем в кровати, - так и должно быть.
4. Чем продолжительнее было голодание, тем эффективнее работает кишечник после того, как оно завершено.
5. Лучшие слабительные продукты, которые рекомендуется употреблять после голодания, - это всяческие свежие сладкие фрукты: вишни, виноград, яблоки и др. На втором месте - квашеные или тушеные сливы. Внимание! Это совет только для людей, которые определенное время жили на бесслизистых или на обедненных слизью продуктах, т.е. на «диете перехода».
6. Если первая пища не создает неприятностей, вы можете есть столько, сколько захотите. Потребление очень маленького количества пищи на протяжении первых 2 или 3 дней без испражнений, что является следствием недостаточного питания, опасно. Это еще один неправильный совет «экспертов»!
7. Если вы поели фруктов, но через час после этого не ощущаете движения в кишечнике, то съешьте еще фруктов или сырых или приготовленных (вареные, тушеные, но не жареные) некрахмалистых овощей. Ешьте до тех пор, пока с первым испражнением не выйдет мусор, накопленный во время голодания. Организм, свободный от всех отходов и ядов, при условии, когда никакие твердые продукты не употребляются внутрь, функционирует без препятствий. Если "база" Вашей крови сформирована из элементов продуктов, которые я преподаю, то Ваш мозг будет функционировать удивительным для Вас образом. Ваша прежняя жизнь будет казаться сном, и впервые в Вашем существовании, сознание пробудится до уровня "реального самосознания".Ваш ум, Ваши размышления, Ваши идеалы и стремления, Ваша философия изменятся основательно и таким способом который слов не хватит описать.Ваша душа будет кричать от радости и одерживать победу над всем страданием жизни, оставляя его позади Вас. Впервые Вы будете чувствовать восхитительно сотрясающую вибрацию жизненной силы, проходящую через Ваше тело (как слабый электрический ток).Вы изучите и поймете, что голодание и Высшее голодание (а не тома по психологии и философии) — единственный и реальный ключ к Высшей жизни — к обретению духовного мира.

Последствие неправильного питания: скопление слизи...
2 лет назад от Сыроедение - Я ФРУКТОРИАНЕЦ
Последствие неправильного питания: скопление слизи в организме
Многие проблемы человеческого здоровья коренятся в переполненной отходами выделительной системе организма. В большинстве случаев закупорка происходит за счет слизи. А сами вы свободны от слизи? Задумайтесь об этом. Скапливается ли слизь в вашей носоглотке? Сколько раз вдень вы достаете носовой платок? сколько раз выплевываете слизь и мокроту?
Любой человек, живущий на обычной пище, страдает от того, что его выделительная система забита слизью. Эта ядовитая слизь образуется из остатков непереваренной и неудаленной ненатуральной пищи, накапливаемой с момента рождения. Она не только закупоривает нос, горло и легкие, но и может быть обнаружена на всем протяжении пищеварительного тракта, начиная от ротовой полости и заканчивая анусом.
Современный рацион слизеобразующий.
Большинство цивилизованных диет основано на жаренной пище, а вся жареная пища слизеобразующая. Молочные продукты также образуют слизь. Когда кровь, заполненная отходами жизнедеятельности паразитов, возвращается в сердце через вены, она сразу же прокачивается через легочную артерию в легкие. Здесь кровь выделяет двуокись углерода и поглощает животворящий кислород. Кислород учувствует в процессах пищеварения и выведения токсинов. Прогулки на свежем воздухе должны быть ежедневного моциона, так как это способствует сохранению здоровья.
Доктора гигиенисты, натуропаты, диетологи сходятся во мнении, что большинство болезней происходит от накопления в организме продуктов распада токсинов. Так называемые простудные заболевания — бронхиты (в т.ч. астматические), ОРЗ, катары, простуды, кашель, ларингиты, плевриты, эмфизема, а также, сенная лихорадка, аллергии связаны с попытками организма освободиться от шлаков и слизи в дыхательных путях.
Американский доктор натуропат Норманн Уокер характеризует все вышеперечисленные таким образом:
Аденоиды — воспаление или увеличение миндальных желез в результате задержки и скопления в организме различных шлаков.
Ангина — воспаление горла, вызванное наличием в организме большого количества продуктов распада и отходов пищи.
Астма — накопление слизи в бронхах приводит к затрудненному дыханию. Для эффективного лечения необходимо отказаться от пищи и напитков, образующих слизь (молоко и молочные продукты, белый хлеб, практически вся концентрированная и богатая углеводами пища.) Безполезно прятаться от аллергенов, принимать лекарства против аллергии и сдавать анализы. Заболевание вызвано исключительно скоплением слизи, от которой нужно избавиться правильной организацией питания.
Бронхит развивается из-за накопления в организме слизи.
Воспаление легких происходит из-за чрезмерного накопления слизи и других отходов. Грипп вызывается чрезмерным накоплением в организме отходов пищи и продуктов обмена, являющихся благоприятной питательной средой для размножения действующих на дыхательные органы патогенных бактерий.
Катар — обильное выделение слизи из слизистой оболочки. Подобные явления развиваются из-за того, что организм отказывается усваивать молочные продукты и концентрированные крахмалы.
Кашель чаще всего бывает связан с попытками организма избавиться от слизи в дыхательных путях.
Ларингит — воспаление дыхательного горла, вызванное наличием шлаков в организме.
Простуда — то же самое, что катар, только в более слабой форме. Лучше предотвратить простуду путем очищения организма от слизи и других шлаков, после чего следует перейти на пищу, состоящую из сырых фруктов, овощей, а также, свежих соков, которая не способствует образованию слизи. Лекарства, прививки и инъекции, как правило, не приносят желаемых результатов.
Ринит — воспаление оболочки носа, вызванное большим количеством слизи в синусоидных углублениях. (Норманн Уокер Лечение соками, Санкт Петербург, 2007г.)
Гарри Бенджамин, доктор, натуропат, США:
Для поддержания в организме нормальных процессов обмена, ему необходимо определенное количество белков, углеводов и жиров. К сожалению, эти продукты оставляют в организме побочные кислотные вещества как результат метаболизма в тканях. Большое количества хлеба, сахара, картофеля, очищенных круп, мяса молочных продуктов приводит к накоплению в организме отбросов с кислотной реакцией.
Поль Брэгг: Да, мне понадобились все эти годы, чтобы открыть замечательный факт, что наша кровь должна иметь щелочную реакцию. От головной боли и несварения желудка до обычного насморка большинство наших болезней — следствие аутоинтоксикации. Когда кровь столь сильно загрязнена, то как мы можем защитить себя от болезнетворных микробов? Как же очистить свою кровь? Это можно сделать, насыщая свою кровь щелочными компонентами. Продукты, имеющие щелочную реакцию — свежие овощи и фрукты, в т.ч. в салатах вместе с зеленью. 60% вашего рациона должно состоять из овощей и фруктов, как сырых, так и приготовленных. Перед любым приемом пищи съешьте сырой овощ или фрукт, салат или свежий сок. Преимущественно кислотная реакция вашей крови будут противиться такому выбору до тех пор, пока организм не очистится от токсинов.
Эти и другие доктора — натуропаты основывали свои теории на многолетних наблюдениях над больными. Их теории во многом основаны на физиологических экспериментах русского академика Павлова, который первым разложил процесс пищеварения на составляющие, изучил состав и качество желудочного сока, используемого для переработки разнообразной пищи. Отсюда он делал выводы о совместимости продуктов, оптимальных режимах приготовления и составе пищи.
В мире нет доктора диетолога, натуропата, который бы не отверг жаренную на масле, переваренную, рафинированную пищу. Также сильно повреждает качество пищи тушение и варка в открытой посуде, использование соли, сахара, искусственных приправ и усилителей вкуса.
Слизь накапливается в организме независимо от регулярного опорожнения кишечника. Кишечные ворсинки способны удерживать липкие вещества, попадающие в кишечник. Стенки кишечника со временем покрываются так называемой липкой и грязной плёнкой. Питательные вещества проходят через этот грязный фильтр прежде чем попасть в кровяное русло, в результате чего даже пища высокого качества деградирует и теряет полезные свойства.
Любой человек, включая тех, кто считает себя абсолютно здоровым, начиная с детского возраста накапливает определённое количество отходных материалов. По статистике, почти у 60% умерших людей в толстом кишечнике наблюдаются отложения весом 6-7 и более килограмм!
Слизь является прекрасным местом для размножения и жизнедеятельности болезнетворных бактерий. Головная боль непонятной этиологии имеет прямую связь с накоплением слизи в организме. Простуда и насморк – результат работы организма по выведению слизи из головы, горла и бронхов. Воспаление лёкгих – серьёзное заболевание, сигналит о проникновении слизи в более глубокие отделы организма. Ревматизм — накопление слизи и мочевой кислоты, как результат — плохая циркуляция жизненной энергии. Через фурункулы и угри кожа пытается вывести вредные накопления. Тугоухость или глухота могут появится в результате закупорки слизью ушных каналов. Запор — избыток слизи в кишечнике.
Пища, которую мы едим является основным фактором накопления избытка слизевых отложений в организме. Существуют слизеобразующие продукты и продукты, обладающие способностью растворять слизь.
Продукты, образующие слизь : Рыба, красная рыба, моллюски, курица, свинина, говядина, телятина, сало, ветчина, яйца, сыр, сливочное масло, маргарин Рис белый и неочищенный, овсяные хлопья, хлеб белый и цельнозерновой, макаронные изделия, ячмень, сухой горох и фасоль, шоколад и сладости, пиво.
Слизерастворяющие продукты : Шпинат, латук, свежие помидоры, огурец, свёкла, репа белая, топинамбур, капуста, свежий горошек, артишок, цикорий, спаржа, тыква, финики, изюм, лимон, апельсин, виноград, черника, слива, персик, малина, абрикос, банан, вишня, гранат, ананас, арбуз, груша, ягоды, кокос, оливки.
Запомните: болезни легче предотвратить, чем лечить. И ради здоровья стоит пересмотреть свой рацион питания. Повторюсь, что не менее 60% вашей пищи должны составлять овощи и фрукты (в основном сырые, без термической обработки). Человек – существо с силой воли, за две недели нового рациона, основанного на натуральных продуктах, вы забудете о недомоганиях и быстро привыкнете к новому образу жизни и питания. Главное – желание!
Многие проблемы человеческого здоровья коренятся в переполненной отходами выделительной системе организма. В большинстве случаев закупорка происходит за счет слизи. А сами вы свободны от слизи? Задумайтесь об этом. Скапливается ли слизь в вашей носоглотке? Сколько раз вдень вы достаете носовой платок? сколько раз выплевываете слизь и мокроту?
Любой человек, живущий на обычной пище, страдает от того, что его выделительная система забита слизью. Эта ядовитая слизь образуется из остатков непереваренной и неудаленной ненатуральной пищи, накапливаемой с момента рождения. Она не только закупоривает нос, горло и легкие, но и может быть обнаружена на всем протяжении пищеварительного тракта, начиная от ротовой полости и заканчивая анусом.
Современный рацион слизеобразующий.
Большинство цивилизованных диет основано на жаренной пище, а вся жареная пища слизеобразующая. Молочные продукты также образуют слизь. Когда кровь, заполненная отходами жизнедеятельности паразитов, возвращается в сердце через вены, она сразу же прокачивается через легочную артерию в легкие. Здесь кровь выделяет двуокись углерода и поглощает животворящий кислород. Кислород учувствует в процессах пищеварения и выведения токсинов. Прогулки на свежем воздухе должны быть ежедневного моциона, так как это способствует сохранению здоровья.
Доктора гигиенисты, натуропаты, диетологи сходятся во мнении, что большинство болезней происходит от накопления в организме продуктов распада токсинов. Так называемые простудные заболевания — бронхиты (в т.ч. астматические), ОРЗ, катары, простуды, кашель, ларингиты, плевриты, эмфизема, а также, сенная лихорадка, аллергии связаны с попытками организма освободиться от шлаков и слизи в дыхательных путях.
Американский доктор натуропат Норманн Уокер характеризует все вышеперечисленные таким образом:
Аденоиды — воспаление или увеличение миндальных желез в результате задержки и скопления в организме различных шлаков.
Ангина — воспаление горла, вызванное наличием в организме большого количества продуктов распада и отходов пищи.
Астма — накопление слизи в бронхах приводит к затрудненному дыханию. Для эффективного лечения необходимо отказаться от пищи и напитков, образующих слизь (молоко и молочные продукты, белый хлеб, практически вся концентрированная и богатая углеводами пища.) Безполезно прятаться от аллергенов, принимать лекарства против аллергии и сдавать анализы. Заболевание вызвано исключительно скоплением слизи, от которой нужно избавиться правильной организацией питания.
Бронхит развивается из-за накопления в организме слизи.
Воспаление легких происходит из-за чрезмерного накопления слизи и других отходов. Грипп вызывается чрезмерным накоплением в организме отходов пищи и продуктов обмена, являющихся благоприятной питательной средой для размножения действующих на дыхательные органы патогенных бактерий.
Катар — обильное выделение слизи из слизистой оболочки. Подобные явления развиваются из-за того, что организм отказывается усваивать молочные продукты и концентрированные крахмалы.
Кашель чаще всего бывает связан с попытками организма избавиться от слизи в дыхательных путях.
Ларингит — воспаление дыхательного горла, вызванное наличием шлаков в организме.
Простуда — то же самое, что катар, только в более слабой форме. Лучше предотвратить простуду путем очищения организма от слизи и других шлаков, после чего следует перейти на пищу, состоящую из сырых фруктов, овощей, а также, свежих соков, которая не способствует образованию слизи. Лекарства, прививки и инъекции, как правило, не приносят желаемых результатов.
Ринит — воспаление оболочки носа, вызванное большим количеством слизи в синусоидных углублениях. (Норманн Уокер Лечение соками, Санкт Петербург, 2007г.)
Гарри Бенджамин, доктор, натуропат, США:
Для поддержания в организме нормальных процессов обмена, ему необходимо определенное количество белков, углеводов и жиров. К сожалению, эти продукты оставляют в организме побочные кислотные вещества как результат метаболизма в тканях. Большое количества хлеба, сахара, картофеля, очищенных круп, мяса молочных продуктов приводит к накоплению в организме отбросов с кислотной реакцией.
Поль Брэгг: Да, мне понадобились все эти годы, чтобы открыть замечательный факт, что наша кровь должна иметь щелочную реакцию. От головной боли и несварения желудка до обычного насморка большинство наших болезней — следствие аутоинтоксикации. Когда кровь столь сильно загрязнена, то как мы можем защитить себя от болезнетворных микробов? Как же очистить свою кровь? Это можно сделать, насыщая свою кровь щелочными компонентами. Продукты, имеющие щелочную реакцию — свежие овощи и фрукты, в т.ч. в салатах вместе с зеленью. 60% вашего рациона должно состоять из овощей и фруктов, как сырых, так и приготовленных. Перед любым приемом пищи съешьте сырой овощ или фрукт, салат или свежий сок. Преимущественно кислотная реакция вашей крови будут противиться такому выбору до тех пор, пока организм не очистится от токсинов.
Эти и другие доктора — натуропаты основывали свои теории на многолетних наблюдениях над больными. Их теории во многом основаны на физиологических экспериментах русского академика Павлова, который первым разложил процесс пищеварения на составляющие, изучил состав и качество желудочного сока, используемого для переработки разнообразной пищи. Отсюда он делал выводы о совместимости продуктов, оптимальных режимах приготовления и составе пищи.
В мире нет доктора диетолога, натуропата, который бы не отверг жаренную на масле, переваренную, рафинированную пищу. Также сильно повреждает качество пищи тушение и варка в открытой посуде, использование соли, сахара, искусственных приправ и усилителей вкуса.
Слизь накапливается в организме независимо от регулярного опорожнения кишечника. Кишечные ворсинки способны удерживать липкие вещества, попадающие в кишечник. Стенки кишечника со временем покрываются так называемой липкой и грязной плёнкой. Питательные вещества проходят через этот грязный фильтр прежде чем попасть в кровяное русло, в результате чего даже пища высокого качества деградирует и теряет полезные свойства.
Любой человек, включая тех, кто считает себя абсолютно здоровым, начиная с детского возраста накапливает определённое количество отходных материалов. По статистике, почти у 60% умерших людей в толстом кишечнике наблюдаются отложения весом 6-7 и более килограмм!
Слизь является прекрасным местом для размножения и жизнедеятельности болезнетворных бактерий. Головная боль непонятной этиологии имеет прямую связь с накоплением слизи в организме. Простуда и насморк – результат работы организма по выведению слизи из головы, горла и бронхов. Воспаление лёкгих – серьёзное заболевание, сигналит о проникновении слизи в более глубокие отделы организма. Ревматизм — накопление слизи и мочевой кислоты, как результат — плохая циркуляция жизненной энергии. Через фурункулы и угри кожа пытается вывести вредные накопления. Тугоухость или глухота могут появится в результате закупорки слизью ушных каналов. Запор — избыток слизи в кишечнике.
Пища, которую мы едим является основным фактором накопления избытка слизевых отложений в организме. Существуют слизеобразующие продукты и продукты, обладающие способностью растворять слизь.
Продукты, образующие слизь : Рыба, красная рыба, моллюски, курица, свинина, говядина, телятина, сало, ветчина, яйца, сыр, сливочное масло, маргарин Рис белый и неочищенный, овсяные хлопья, хлеб белый и цельнозерновой, макаронные изделия, ячмень, сухой горох и фасоль, шоколад и сладости, пиво.
Слизерастворяющие продукты : Шпинат, латук, свежие помидоры, огурец, свёкла, репа белая, топинамбур, капуста, свежий горошек, артишок, цикорий, спаржа, тыква, финики, изюм, лимон, апельсин, виноград, черника, слива, персик, малина, абрикос, банан, вишня, гранат, ананас, арбуз, груша, ягоды, кокос, оливки.
Запомните: болезни легче предотвратить, чем лечить. И ради здоровья стоит пересмотреть свой рацион питания. Повторюсь, что не менее 60% вашей пищи должны составлять овощи и фрукты (в основном сырые, без термической обработки). Человек – существо с силой воли, за две недели нового рациона, основанного на натуральных продуктах, вы забудете о недомоганиях и быстро привыкнете к новому образу жизни и питания. Главное – желание!

КАК УБИТЬ В СЕБЕ ПОТРЕБИТЕЛЯ: ОПЫТ ЧЕЛОВЕКА С...
2 лет назад от Сыроедение - Я ФРУКТОРИАНЕЦ
КАК УБИТЬ В СЕБЕ ПОТРЕБИТЕЛЯ: ОПЫТ ЧЕЛОВЕКА С ДЕНЬГАМИ
Я живу в студии площадью 39 квадратных метров. Я сплю на выдвижной кровати, встроенной в стену. У меня 6 рубашек. 10 чеплашек для салатов и прочих блюд. Когда гости приходят ко мне на ужин, я достаю раскладной стол. У меня нет DVD, а текущая коллекция книг составляет 10% от изначальной.
Я прошёл долгий путь с конца 90-х, когда успешный интернет-стартап обернулся для меня огромным потоком денег. Тогда я купил гигантский дом и забил его вещами, электроникой, бытовой техникой, гаджетами, организовал свой автопарк. Но каким-то образом всё это добро заняло собой мою собственную жизнь, ну или большую её часть. Вещи, которые я потреблял, поглощал, в итоге поглотили меня. Да, у меня не самый распространённый жизненный сценарий, ведь мало кто сильно обогащается к 30 годам, но мой сценарий взаимодействия с вещами - самый обычный.
Мы живём в избытке товаров, в мире гипермаркетов, огромных торговых центров и круглосуточных магазинов. Люди практически любой социальной прослойки могут окружить себя вещами. Не существует какого-либо признака, указывающего на то, что эти вещи делают нас счастливыми. Фактически, я наблюдаю обратную картину. Мне понадобилось 15 лет, чтобы избавиться от всего несущественного, что я так старательно накапливал, и начать жить шире, свободнее, лучше, обладая меньшим.
Всё началось в 1998 году. Я и мой партнёр продали нашу консалтинговую компанию за такую сумму, которую, как мне казалось, я не заработаю за всю свою жизнь. Получив такую сумму, я купил 4-этажный дом. Охваченный открывшейся возможностью потреблять, я купил новенький секционный диван, пару очков по $300, тонну гаджетов и аудиофильский 5-дисковый CD-плеер. И, конечно же, чёрный заряженный Volvo с дистанционным запуском двигателя. Я начал активно работать над новой компанией, и времени на дом совсем не оставалось. Тогда я нанял парня по имени Сэвен, который, по его словам, работал ассистентом самой Кортни Лав. Он стал моим ассистентом по покупкам. Его роль заключалась в походах по магазинам бытовой техники, электроники и фурнитуры с фотоаппаратом. Он фотографировал вещи, которые, на его взгляд, приглянулись бы мне, после чего я просматривал фото вещей и выбирал понравившиеся мне для покупки.
Однако потребительский наркотик в скором времени перестал вызывать эйфорию. Я охладел ко всему. Новенькая Nokia не возбуждала и не удовлетворяла меня. Я начал размышлять о том, почему улучшения в жизни, которые в теории должны были сделать меня счастливее, не помогают, а лишь создают в голове чувство тревоги. Жизнь стала сложнее. Столько всего, за чем надо следить. Газон, уборка, автомобиль, страховка, обслуживание. У Сэвена было много работы, и… В конце концов, у меня персональный ассистент по покупкам? В кого я превратился?! Мой дом и мои вещи стали моими новыми работодателями, причём я к ним не хотел наниматься. Всё стало ещё хуже.
Я переехал по работе в Нью-Йорк и арендовал большой дом, служивший хорошим отражением меня как IT-предпринимателя. Дом нужно было заполнить вещами, и это затратно по силам и времени. А ещё у меня был дом в Сиэтле. Я должен был думать о двух домах. Когда я решил, что останусь в Нью-Йорке, потребовались колоссальные усилия и куча перелётов туда-сюда, чтобы закрыть вопрос со старым домом и избавиться от всех вещей, находившихся в нём. Очевидно, что мне повезло с деньгами, но подобные проблемы свойственны многим.
Исследование «Жизнь дома в 21 веке» демонстрирует жизнь 32 семей из среднего класса. Необходимость заботиться о своём имуществе гарантированно вызывает выработку гормона стресса. 75% семей не могли парковать машину в гараже, потому что гараж забит другими вещами. Наша любовь к вещам затрагивает практически каждый аспект нашей жизни.
Делает ли всё это вас счастливее? Есть ещё один момент - социально-психологический. Наблюдения Галена Боденхаузена, психолога из Северо-Западного университета в Иллинойсе, однозначно связывают потребление и аномальное, антиобщественное поведение. Потребительский склад ума в одинаковой степени негативен для человека независимо от его уровня дохода.
Интуитивно мы понимаем, что лучшие вещи в жизни - это не те самые «вещи», а отношения, опыт и достижение целей. Они являются продуктами счастливой жизни.
Мне нравятся материальные объекты. Я изучал дизайн, я люблю гаджеты и одежду, и подобные вещи. Но мой опыт показывает, что с определённого момента материальные объекты вытесняются эмоциональными потребностями, которые эти объекты, в теории, должны поддерживать.
Я по-прежнему предприниматель и сейчас занимаюсь разработкой продуманных компактных домов. Эти дома создаются так, чтобы они поддерживали нашу жизнь, а не наоборот. Подобно тем 39 квадратным метрам, в которых живу я, эти дома не требуют большого количества материалов для строительства, не требуют серьёзных затрат на содержание, позволяя владельцу жить экономнее. Я хорошо сплю, потому что знаю, что не использую больше ресурсов, чем мне действительно необходимо. У меня меньше вещей, но больше наслаждения. Мало места - много жизни.
Грэм Хилл
Я живу в студии площадью 39 квадратных метров. Я сплю на выдвижной кровати, встроенной в стену. У меня 6 рубашек. 10 чеплашек для салатов и прочих блюд. Когда гости приходят ко мне на ужин, я достаю раскладной стол. У меня нет DVD, а текущая коллекция книг составляет 10% от изначальной.
Я прошёл долгий путь с конца 90-х, когда успешный интернет-стартап обернулся для меня огромным потоком денег. Тогда я купил гигантский дом и забил его вещами, электроникой, бытовой техникой, гаджетами, организовал свой автопарк. Но каким-то образом всё это добро заняло собой мою собственную жизнь, ну или большую её часть. Вещи, которые я потреблял, поглощал, в итоге поглотили меня. Да, у меня не самый распространённый жизненный сценарий, ведь мало кто сильно обогащается к 30 годам, но мой сценарий взаимодействия с вещами - самый обычный.
Мы живём в избытке товаров, в мире гипермаркетов, огромных торговых центров и круглосуточных магазинов. Люди практически любой социальной прослойки могут окружить себя вещами. Не существует какого-либо признака, указывающего на то, что эти вещи делают нас счастливыми. Фактически, я наблюдаю обратную картину. Мне понадобилось 15 лет, чтобы избавиться от всего несущественного, что я так старательно накапливал, и начать жить шире, свободнее, лучше, обладая меньшим.
Всё началось в 1998 году. Я и мой партнёр продали нашу консалтинговую компанию за такую сумму, которую, как мне казалось, я не заработаю за всю свою жизнь. Получив такую сумму, я купил 4-этажный дом. Охваченный открывшейся возможностью потреблять, я купил новенький секционный диван, пару очков по $300, тонну гаджетов и аудиофильский 5-дисковый CD-плеер. И, конечно же, чёрный заряженный Volvo с дистанционным запуском двигателя. Я начал активно работать над новой компанией, и времени на дом совсем не оставалось. Тогда я нанял парня по имени Сэвен, который, по его словам, работал ассистентом самой Кортни Лав. Он стал моим ассистентом по покупкам. Его роль заключалась в походах по магазинам бытовой техники, электроники и фурнитуры с фотоаппаратом. Он фотографировал вещи, которые, на его взгляд, приглянулись бы мне, после чего я просматривал фото вещей и выбирал понравившиеся мне для покупки.
Однако потребительский наркотик в скором времени перестал вызывать эйфорию. Я охладел ко всему. Новенькая Nokia не возбуждала и не удовлетворяла меня. Я начал размышлять о том, почему улучшения в жизни, которые в теории должны были сделать меня счастливее, не помогают, а лишь создают в голове чувство тревоги. Жизнь стала сложнее. Столько всего, за чем надо следить. Газон, уборка, автомобиль, страховка, обслуживание. У Сэвена было много работы, и… В конце концов, у меня персональный ассистент по покупкам? В кого я превратился?! Мой дом и мои вещи стали моими новыми работодателями, причём я к ним не хотел наниматься. Всё стало ещё хуже.
Я переехал по работе в Нью-Йорк и арендовал большой дом, служивший хорошим отражением меня как IT-предпринимателя. Дом нужно было заполнить вещами, и это затратно по силам и времени. А ещё у меня был дом в Сиэтле. Я должен был думать о двух домах. Когда я решил, что останусь в Нью-Йорке, потребовались колоссальные усилия и куча перелётов туда-сюда, чтобы закрыть вопрос со старым домом и избавиться от всех вещей, находившихся в нём. Очевидно, что мне повезло с деньгами, но подобные проблемы свойственны многим.
Исследование «Жизнь дома в 21 веке» демонстрирует жизнь 32 семей из среднего класса. Необходимость заботиться о своём имуществе гарантированно вызывает выработку гормона стресса. 75% семей не могли парковать машину в гараже, потому что гараж забит другими вещами. Наша любовь к вещам затрагивает практически каждый аспект нашей жизни.
Делает ли всё это вас счастливее? Есть ещё один момент - социально-психологический. Наблюдения Галена Боденхаузена, психолога из Северо-Западного университета в Иллинойсе, однозначно связывают потребление и аномальное, антиобщественное поведение. Потребительский склад ума в одинаковой степени негативен для человека независимо от его уровня дохода.
Интуитивно мы понимаем, что лучшие вещи в жизни - это не те самые «вещи», а отношения, опыт и достижение целей. Они являются продуктами счастливой жизни.
Мне нравятся материальные объекты. Я изучал дизайн, я люблю гаджеты и одежду, и подобные вещи. Но мой опыт показывает, что с определённого момента материальные объекты вытесняются эмоциональными потребностями, которые эти объекты, в теории, должны поддерживать.
Я по-прежнему предприниматель и сейчас занимаюсь разработкой продуманных компактных домов. Эти дома создаются так, чтобы они поддерживали нашу жизнь, а не наоборот. Подобно тем 39 квадратным метрам, в которых живу я, эти дома не требуют большого количества материалов для строительства, не требуют серьёзных затрат на содержание, позволяя владельцу жить экономнее. Я хорошо сплю, потому что знаю, что не использую больше ресурсов, чем мне действительно необходимо. У меня меньше вещей, но больше наслаждения. Мало места - много жизни.
Грэм Хилл

Игpушки в киндepах нe обнapужeны)))
2 лет назад от Я люблю и хочу быть с тобой одной семьёй
Игpушки в киндepах нe обнapужeны)))

Я нe прoтив, чтобы мой cын οтдал дoлг нашему госудаpству...
2 лет назад от Я люблю и хочу быть с тобой одной семьёй
Я нe прoтив, чтобы мой cын οтдал дoлг нашему госудаpству в apмии! HΟ!!!!!! Зa рοды я заплатила - CAМA, за сад - CΑMΑ, за шκолу - СΑΜΑ, за обучение -СΑМΑ. Кopмилa, οдeвала, лечила -СAΜAAAAAAAAAAAAAAA!!! откуда ДOΛΓ - HE пoйму!!!

Тoлькo paди peбeнка жeнщина мoжeт пожepтвовать гpyдью, животом, бедpами и жизнью
2 лет назад от Я люблю и хочу быть с тобой одной семьёй
Тoлькo paди peбeнка жeнщина мoжeт пожepтвовать гpyдью, животом, бедpами и жизнью

Да, а еще быть мамой - тяжелый труд! l????l
2 лет назад от Я люблю и хочу быть с тобой одной семьёй
Да, а еще быть мамой - тяжелый труд! l????l

Мамы у которых тройняшки, героини. Я с одним еле справляюсь????
2 лет назад от Я люблю и хочу быть с тобой одной семьёй
Мамы у которых тройняшки, героини. Я с одним еле справляюсь????

Cвoй тpидцaть пepвый гoд жизни, вcтpeтилa мoмeнтaльнoй...
2 лет назад от Я люблю и хочу быть с тобой одной семьёй
Cвoй тpидцaть пepвый гoд жизни, вcтpeтилa мoмeнтaльнoй кoнчинoй.
B oднoм из дoмoв Cибиpcкoгo гopoдa cнecлo чacть квapтиp дoмa. Чacть здaния былa cнeceнa. Myжчинa пpиexaл нa мecтo кaк тoлькo yзнaл нoвocть. Oн cpaзy yвидeл, чтo имeннo eгo квapтиpa paзpyшeнa, пoэтoмy cpaзy жe кинyлcя нa пoмoщь cпacaтeлям. Bыяcнилocь, чтo пoд oблoмкaми нaxoдилacь eгo жeнa и peбёнoк. Oн нaдeялcя, чтo oни живы.
Haдeжды нe oпpaвдaлиcь. Cпacaтeли дocтaли бeздыxaннoe тeлo мaлышки, a пoзжe и пoгибшyю cyпpyгy. B тoт дeнь eй иcпoлнилcя тpидцaть oдин гoд.
#дети #семья
B oднoм из дoмoв Cибиpcкoгo гopoдa cнecлo чacть квapтиp дoмa. Чacть здaния былa cнeceнa. Myжчинa пpиexaл нa мecтo кaк тoлькo yзнaл нoвocть. Oн cpaзy yвидeл, чтo имeннo eгo квapтиpa paзpyшeнa, пoэтoмy cpaзy жe кинyлcя нa пoмoщь cпacaтeлям. Bыяcнилocь, чтo пoд oблoмкaми нaxoдилacь eгo жeнa и peбёнoк. Oн нaдeялcя, чтo oни живы.
Haдeжды нe oпpaвдaлиcь. Cпacaтeли дocтaли бeздыxaннoe тeлo мaлышки, a пoзжe и пoгибшyю cyпpyгy. B тoт дeнь eй иcпoлнилcя тpидцaть oдин гoд.
#дети #семья

- Что такое счастье? Где его купить?- Счастье?... Нет, его не купишь! Счастье можно лишь родить!
2 лет назад от Я люблю и хочу быть с тобой одной семьёй
- Что такое счастье? Где его купить?
- Счастье?... Нет, его не купишь! Счастье можно лишь родить!
- Счастье?... Нет, его не купишь! Счастье можно лишь родить!

Жизненная правда!))l????l
2 лет назад от Я люблю и хочу быть с тобой одной семьёй
Жизненная правда!))l????l




И не поспоришь! l????l
2 лет назад от Я люблю и хочу быть с тобой одной семьёй
И не поспоришь! l????l

Нашли очень интересное сходство. Монгол в молодости...
2 лет назад от Я смотрю «Пацанки» и радуюсь жизни
Нашли очень интересное сходство. Монгол в молодости или дочь монгола. Как будто фильтр baby face включают.

Так выглядела Рони в юности. Изменения колоссальные и сейчас девушка выглядит гораздо ярче.
2 лет назад от Я смотрю «Пацанки» и радуюсь жизни
Так выглядела Рони в юности. Изменения колоссальные и сейчас девушка выглядит гораздо ярче.

Прекрасная Анечка из которой бы получилось отличная...
2 лет назад от Я смотрю «Пацанки» и радуюсь жизни
Прекрасная Анечка из которой бы получилось отличная модель. Очень хорошие черты лица, в любом образе будет девочка выглядеть великолепно!


Когда пытаешься быть более женственной и напяливаешь одежду, которая тебе не нравится.
2 лет назад от Я смотрю «Пацанки» и радуюсь жизни
Когда пытаешься быть более женственной и напяливаешь одежду, которая тебе не нравится.



Ау, в которой Тодороки воспитывает ребенка погибших героев
2 лет назад от Типичный Лемур (Аниме и Комиксы)
Ау, в которой Тодороки воспитывает ребенка погибших героев


Идeя для дyшевoй, чтобы поcидeть и раccлабитьсяДизайн и Ремонт от А до Я!
2 лет назад от Дизайн и Ремонт от А до Я
Идeя для дyшевoй, чтобы поcидeть и раccлабиться
Дизайн и Ремонт от А до Я!
Дизайн и Ремонт от А до Я!






Кoмната маленькая,a мaльчишeк тpoe! Ηaшли peшeние!Дизайн и Ремонт от А до Я!
2 лет назад от Дизайн и Ремонт от А до Я
Кoмната маленькая,a мaльчишeк тpoe! Ηaшли peшeние!
Дизайн и Ремонт от А до Я!
Дизайн и Ремонт от А до Я!

Πо-мужскиДизайн и Ремонт от А до Я!
2 лет назад от Дизайн и Ремонт от А до Я
Πо-мужски
Дизайн и Ремонт от А до Я!
Дизайн и Ремонт от А до Я!

Κак же я завидую своим coсeдям...Дизайн и Ремонт от А до Я!
2 лет назад от Дизайн и Ремонт от А до Я
Κак же я завидую своим coсeдям...
Дизайн и Ремонт от А до Я!
Дизайн и Ремонт от А до Я!

От тaкoй кухни я бы нe oткaзaлacь)))Дизайн и Ремонт от А до Я!
2 лет назад от Дизайн и Ремонт от А до Я
От тaкoй кухни я бы нe oткaзaлacь)))
Дизайн и Ремонт от А до Я!
Дизайн и Ремонт от А до Я!

Жена зaxoтeла имeнно в такиx цвeтax))Дизайн и Ремонт от А до Я!
2 лет назад от Дизайн и Ремонт от А до Я
Жена зaxoтeла имeнно в такиx цвeтax))
Дизайн и Ремонт от А до Я!
Дизайн и Ремонт от А до Я!



Теперь у меня куча плакатов) качество хорошее????#КицунэОтзыв
2 лет назад от Аниме магазин "Кицунэ" Иркутск
Теперь у меня куча плакатов) качество хорошее????
#КицунэОтзыв
#КицунэОтзыв









Спешим порадовать новой и старой, но любимой мангой!...
2 лет назад от Аниме магазин "Кицунэ" Иркутск
Спешим порадовать новой и старой, но любимой мангой! ❤️
Итак, уже завтра вы можете приобрести вот эти замечательные томики ????
Итак, уже завтра вы можете приобрести вот эти замечательные томики ????








Вчера наконец-то спустя долгое время успела к вам...
2 лет назад от Аниме магазин "Кицунэ" Иркутск
Вчера наконец-то спустя долгое время успела к вам забежать. Моей целью были моти, раньше никак не получалось приехать, а тут о чудо ????
Не ожидала, но успела в подарок получить конфетки (даже не знаю, чему рада больше:им или моти). Ну и значок с Мегумин я не могла пропустить, спасибо за пополнение коллекции) Как всегда, все на высшем уровне, консультанты милашки, всегда помогут определиться,наделят хорошим настроением, аж жалко уходить(( ( Надеюсь скоро снова приеду к вам, спасибо большое :3????
#КицунэОтзыв
Не ожидала, но успела в подарок получить конфетки (даже не знаю, чему рада больше:им или моти). Ну и значок с Мегумин я не могла пропустить, спасибо за пополнение коллекции) Как всегда, все на высшем уровне, консультанты милашки, всегда помогут определиться,наделят хорошим настроением, аж жалко уходить(( ( Надеюсь скоро снова приеду к вам, спасибо большое :3????
#КицунэОтзыв


У нас поступление новых красивых и ярких подушечек!...
2 лет назад от Аниме магазин "Кицунэ" Иркутск
У нас поступление новых красивых и ярких подушечек! ????
В данном посте представлен только Геншин. По остальным фандомам подробнее в следующем посте ????
Цена: 900 руб.
В данном посте представлен только Геншин. По остальным фандомам подробнее в следующем посте ????
Цена: 900 руб.






Что нового?
stalker прошел тест: Какой твой беон?
2 дн. назад
stalker оставил(а) комментарий в дневнике Ханджа Зоя к записи:
емае а за шо тебя забанили.............
2 дн. назад















































